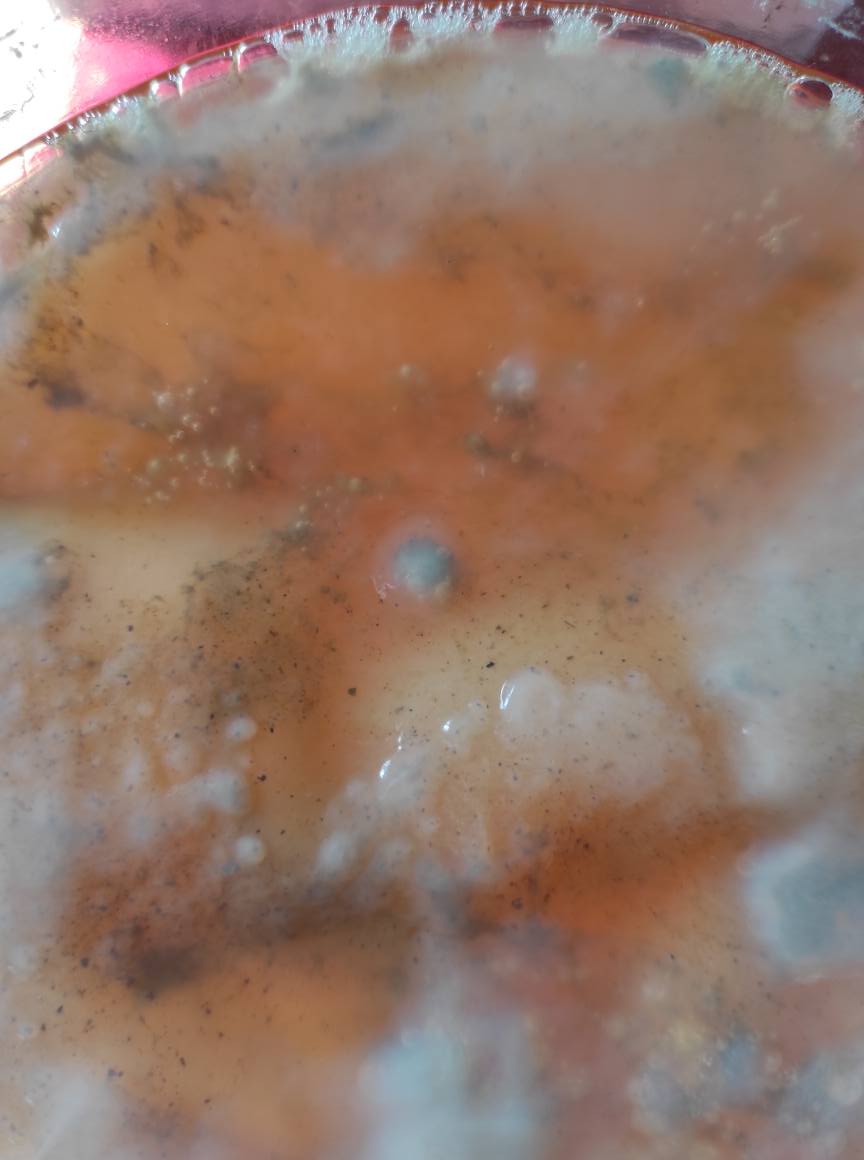

1000+1 kombuchových otázek a odpovědí
| 7. ledna 2024 | přečtete za 61 minut
Tento výčet otázek a odpovědí je kompilátem toho, na co se ptají chovatelé a spotřebitelé ve skupině Kombucha — domácí příprava. Za účelem vyobrazení některých typických fenoménů jsem využil snímky uživatelů zmíněné skupiny, všem autorům a tazatelům tímto děkuji!
Zachovejte paniku!
To je heslo, které opakuju začátečníkům s jejich dotazy a nejistotami, když se ptají na potíže, které ještě nenastaly. Drtivá většina dotazů se totiž zodpoví sama jenom tím, že budete s fermentem pár týdnů nebo měsíců podle základního kombuchového návodu žít, uvidíte běžné jevy a ochutnáte běžné změny chutí a získáte cit. Začínáte-li, zaměřte se jen na kvašení čaje a na dokvášení s ovocem se vyprdněte. O nic nepřijdete a povinnosti se vám smrsknou na vaření sladkého čaje a pití i tak moc dobré čistě čajové kombuchy.
Toto není návod
Jste-li začátečníci, nepokoušejte se tento obrovský úhrn otázek a odpovědí použít jako návod, k tomu sloužit nemá. Chov kultury je mnohem jednodušší, než se může zdát, a mám ho pro své zákazníky připravený na eshopu.
Kombucha není houba, akvarijní rybička ani mimino
Mnoho otazníků a nesprávných úvah se vyřeší tehdy, když začnete správně chápat, co vlastně chováte. Jste zvyklí na domácí zvířátka nebo členy domácnosti, kteří nabývají jen stavů 1 nebo 0. Zapnuto či vypnuto. Žije nebo nežije. Kombuchové společenství je ale úhrn miliard a biliónů mikroorganismů několika (desítek) druhů, které se soustavně mění, má různé nálady, tu je aktivnější jeden druh, ondy zase jiný. Ten celulózový předmět nedýchá, netrpí, neraduje se, nemusí být čistý a vykoupaný. Je to jen hromádka celulózy, kterou produkují octové bakterie, kterých jsou ony miliardy. O ně se staráte, jim připravujete životní prostředí, je krmíte.
Na pojem houba úplně zapomeňte. Houba by byl organismus z říše Fungi, který má svůj metabolismus, rozmnožovací cyklus, buněčné struktury, genetiku. Nic z toho vaše placka nemá, nic z toho neumí. Budete-li o předmětu přemýšlet a hovořit jako o houbě, budete uvádět v nepochopení sebe i své okolí, budou z toho pramenit nereálná a nefunkční očekávání toho, jak se má kultura chovat (v obou smyslech slova). Toto bylo popsáno již ve vědeckých časopisech Mykologia 4/1927, L. Müllerová a Časopis československých houbařů, březen 1928, R. Veselý.
Kombuchová mikroflóra
Hlavní a definující složkou jsou octové bakterie, které oxidují cukry na organické kyseliny (glukonovou, glukuronovou), zároveň mají i schopnost spojovat (polymerovat) cukry a tvořit z nich celulózovou placku na hladině. Hlavním, nejznámějším a nejvýkonnějším zástupcem v produkci celulózy je Komagataeibacter xylinus (dříve Bacterium xylinum) a pravděpodobně je to jediný druh, který je pro kombuchové kultury napříč všemi flaškami spolehlivě společný. Žádný probiotický efekt u něj nebyl prokázán, je aerobní, po konzumaci v trávicím systému uhyne vlivem kyselého pH v žaludku, nedostatku kyslíku a nedostatku jednoduchých dostupných cukrů.
Mohou být přítomny i různé další druhy octových bakterií z rodů Gluconobacter, Gluconacetobacter nebo Acetobacter, míra zastoupení rodů, druhů a kmenů je dílem náhody a tudíž je dílem náhody i poměr a složení produkovaných kyselin (octová, glukonová, glukuronová), vitamínů © a dalších produktů fermentace (alkoholy, estery). Probiotický potenciál je stále velmi nereálný kvůli neschopnosti přežít v lidském trávicím systému kvůli chybění kyslíku nutnému k přežití těchto organismů. V člověku octové bakterie nežijí a nepůsobí.
Jednobuněčné houby — kvasinky — jsou zastoupeny nejčastěji rodem Saccharomyces cerevisiae (pekařská/alkoholová kvasinka), která silně pomáhá invertovat řepný cukr na monosacharidy glukózu a fruktózu, které jsou pak v kultuře dobře dostupné dalším bakteriím a kvasinkám, umí vyrábět alkohol, CO₂ a jako vedlejší produkt i vitamíny skupiny B. Kvasinky nejsou pevnou součástí kultury, ale spíše neodvratnou kontaminací v takové míře, jaká odpovídá aktuálním podmínkám, které zrovna chovatel nastavil. Tyto kvasinky nemají probiotické potvrzené univerzální účinky. Jsou zastoupeny náhodně i další rody jednobuněčných hub, např. Zygosaccharomyces.
Mohou být zastoupeny dílem náhody další mikroorganismy, včetně různých rodů, druhů a kmenů laktobacilů a dalších. Tyto organismy však nejsou pro kulturu určující a jejich přítomnost nelze v domácnosti rozpoznat. Kvůli náhodnosti výskytu je náhodné i složení či probiotický potenciál.
Určitě do spolku nepatří nic jako zázračná houba Medusomyces gisevii, což je mylně popsaný domnělý taxon z roku 1913, kdy si mykolog Gustav Lindau myslel, že zkoumá houbu a netušil, že jde o bakteriální celulózu octových bakterií. Je to dávno vyvráceno a pokud někdo toto označení používá v marketingu, věší vám bulíky na nos.
Slovníček
Bude se nám hodit pár pojmů, abychom dobře kultuře a procesům porozuměli:
- acetobactery jsou celá rodina octových bakterií, které umí z glukózy nebo alkoholu vytvářet kyselinu octovou, některé i celulózu; zahrnují rody Acetobacter, Gluconacetobacter, Gluconobacter či Komagataeibacter
- bakterie (např. mléčné nebo octové) jsou mikroorganismy tyčinkovitého tvaru patřící do (nad)říše prokaryota a nemají nic společného s kvasinkami krom mikroskopické velikosti
- celulóza je ta placka, která plave na hladině nebo spadla ke dnu; upletly ji z jednodušších cukrů octové bakterie, které to umí za pomoci svých enzymů; jedná se o stejné molekuly celulózy, jakou produkují rostliny pro výstavbu svých pletiv, ve vodě je nerozpustná a člověkem nestravitelná
- dcera je slovo, které jsem z celého textu vyhodil, protože naznačuje, že se narodila z matky, což je v případě kombuchy omyl; celulózová placka je jen placka a není dcerou ničeho, vyrábí ji mikroskopické octové bakterie
- houba viz výše, jedinými houbami v kombuchovém společenství jsou okem neviditelné jednobuněčné kvasinky
- jun je nápoj z kombuchové kultury krmené zeleným čajem a medem; není mikrobiálně o nic zvláštnější než jakákoliv jiná kultura krmená čajem
- kombucha je celý koncept octového kysání oslazeného čaje; slovo v japonštině vždy znamenalo, znamená a znamenat bude především prášek nebo odvar z mořské řasy kombu; k přenosu slova na octově zkysaný čaj došlo omylem mezi lety 1921 – 1927 patrně v Praze
- kombuchový nápoj je nápoj, který obsahuje zbytky původního substrátu (sladký čaj), rozprostřené živé či umrtvené bakterie a kvasinky a jejich metabolity (ocet, alkohol aj.)
- kvasinky jsou jednobuněčné houby patřící do říše Fungi, které se živí zpravidla cukrem a rozkládají jej na alkohol a CO₂; kvasinky nemají nic společného s bakteriemi krom mikroskopické velikosti
- matka je slovo, které jsem z celého textu vyhodil, protože naznačuje původce něčeho, což je v případě kombuchy omyl; celulózová placka je jen placka a není matkou ničeho, vyrábí ji neviditelné octové bakterie
- metabolity jsou látky, které mikroorganismy při fermentování cukrů vyprodukují, jsou to různé plyny, kyseliny, alkoholy, celulóza, vitamíny aj.
- násada je dřevěná tyč od hrábí nebo lopaty, nemá s kombuchou nic společného
- red rumi je nápoj z kombuchové kultury krmené ibiškovými květy a šípkovými plody; není mikrobiálně o nic zvláštnější než jakákoliv jiná kultura krmená čajem
- saccharomycety viz kvasinky
- SCOBY je symbiotická kolonie bakterií a kvasinek, tedy společenství různých mikroorganismů bez ohledu na to, jestli plave v čaji, roste v laboratoři na petriho misce nebo je uvězněno v celulózové placce; nejčastějším omylem je nazývat tímto slovem právě placku plovoucí na hladině fermentujícího substrátu; označení SCOBY si totiž zaslouží i symbiotické kolonie bakterií a kvasinek tvořící mléčný kefír, vodní kefír nebo chlebový kvas, a ty žádnou celulózu neprodukují
- Scooby je kreslený pejsek z animovaného seriálu Scooby Doo od studia Hanna-Barbera a nemá s kombuchou nic společného
- scuba anglický termín pro hlubinné potápění scuba diving, nemá s kombuchou nic společného (leda když vám placka klesne ke dnu)
- skoba je kovový háček sloužící k zatlučení do zdi za účelem zavěšení předmětu a nemá s kombuchou nic společného
- startér viz zákvas
- substrát je živné médium, zde pro mikroorganismy nejčastěji čaj s cukrem; čaj je pro mikroby zdrojem dusíku na stavbu bílkovin, cukr zdrojem energie
- zákvas je startér a je to hotový prokysaný nápoj se všemi potřebnými bakteriemi společenství používaný na naočkování příští várky; k zákvasu se přihazuje i celulózová placka.
Ztracené bakterie

Existuje jedna zásadní chyba, které když se při chovu dopustíte, jste v pytli: uvedete příliš malé kombuchové společenství bakterií do příliš velkého množství sladkého čaje. Jakmile toto není v návodu, který jste ke kultuře dostali, vysvětleno a tu chybu učiníte, zaděláte si hned na začátku na problém. Je to bohužel nešvar jak rozdávaných kultur, tak i komerčně prodávaných. Návody obsahují nepřesné a zavádějící termíny (houba, fungus) a předanou kulturu, která je mnohdy vychcípaná a zesláblá dlouhým stáním v regálu bioobchodu, navádějí utopit v příliš velkém objemu sladkého čaje. Začátečník pak sedí u tiché sklenice, kde se nic neděje, pročež za pár dnů se na sladké hladině objeví křís a kulturu už není možné rozpěstovat, protože těch sedmnáct smutných zbývajících bakterií se v litru zcela ztratilo a vzdalo veškerou snahu o rozmnožení. Většinou pak následuje povrchový růst plísně.
Jakmile dostanete do oka poměr celulózové placky a zákvasu z minula vůči připravovanému množství nápoje, jste z toho venku a většina problémů se vám vyhne.
Ještě mnohokrát to zazní, ale do nového sladkého čaje se nehází jenom celulózová placka, ale i 10 % (a klidně i více) živého aktivního zákvasu z minula. Jde to i bez zákvasu jen s plackou či naopak, ale dohromady to funguje nejlépe.
Kombuchová kalkulačka
Nastavte prvním posuvníkem velikost vaší placky a zbytek se vám dopočítá. Další dva posuvníky použijte jen tehdy, chcete-li upravit sílu čaje nebo sladkost.
Pokud vám zákvas chybí a máte jen placku, připravte si zákvas tak, že naložíte na dva dny placku při pokojové teplotě do takového množství sladkého čaje, kolik je zhruba dvojnásobek hmotnosti placky. Pokud tedy vaše placička váží 100 gramů, naložíte ji do 200 gramů snídaňově oslazeného čaje. Tak malé množství by mělo za den či dva hezky prokysat a pak už můžete pokračovat podle kalkulačky s běžnou produkcí.
Pokud máte zákvas extrémně octovatý, pak prostě jen zakládejte s trochu menším množstvím, než ukazuje kalkulačka. V následující várkách průběžně sledujte kyselost a snažte se ji snižovat za stálého ochutnávání kratším kysáním.

Tradice
Jak se to vlastně správně vyslovuje? Není to podstatné, vyslovujte tak, jak jste zvyklí. Většina světa vyslovuje ‑ča po vzoru japonského základu pro slovo čaj (kukicha, genmaicha, koucha, matcha jsou všechno typy čaje). Češi zvyklí na fonetické vyslovování a ovlivnění do té doby němčinou však od roku 1927 vyslovují častěji slabiku česky ‑cha; fundovaně zodpovídá dotaz ÚJČ.
Jak je ta kultura vlastně stará? Odkud pochází? Většina zdrojů pokoušejících se o historické datování od sebe volně opisuje navzájem a i při citacích ve vědeckých článcích se dostávají autoři při odkazování do bludného kruhu. Tisíce i stovky let jsou nedoložitelné. My jsme rešeršovali poctivě, četli jsme dobové ruské, německé a rakouské odborné články i tisk z počátku 20. století a z toho vzešly články Kombuchová historie 1: omyl Medusomyces gisevii a Kombuchová historie 2: omyl s názvem kombucha. Ve zkratce: kulturně a octově zakysaný čaj byl znám z Lotyšska a Ruska teprve z přelomu 19. a 20. století, a to téměř výhradně pod lidovým názvem „houba“ nebo „čajová houba“, k použití slova kombucha pro octově zkysaný čaj došlo mezi lety 1921 až 1927 v Praze. Je téměř jisté, že fenomén nepochází z Japonska ani Koreje. Tam dodnes slovo kombucha (昆布茶) znamená mořskou řasu rozemletou se solí na prášek používanou jako k přípravě vývaru. Kdybyste s Japoncem chtěli konverzovat o fermentované limonádě, museli byste používat termín koucha kinoko (紅茶キノコ (こうちゃキノコ) neboli černý čaj s houbou.
Co se týče mikrobiálního složení a jeho půvdou, pak jde o běžné druhy, které se ve vzduchu vyskytují po celé Zemi a není nijak složité je z jejich přirozeného prostředí pozvat kdekoliv na světě do svého připraveného substrátu, nakultivovat a začít vést jako fermentovanou limonádu. Nemá tedy žádný konkrétní místopisný původ, ze kterého by ji bylo potřeba v průběhu historie přinášet. Na toto téma nabízím články Vypěstoval jsem kombuchu z ničeho a Ta pravá kultura.
Konzumace, alkohol, zdraví a probiotika
Je kombucha vhodná pro děti, řidiče, abstinující alkoholiky či těhotné a kojící ženy? Můžu ji při užívání léků, antibiotik? Na to neexistuje jednoznačná odpověď a každý si otázku musí zodpovědět sám podle své konkrétní situace. Jediným problematickým parametrem je množství etanolu, který při bublavém kvašení vzniká. Někdo vede svou limonádu častým opakováním tak, že mu vzniká etanolu opravdu málo, někdo ji vede druhou fermentací a přikrmováním ovocem tak, že vzniká víc. Jedině laboratorní rozbor každé jednotlivé domácí várky spolehlivě stanoví koncentraci alkoholu, přičemž ho musí laboratoř provést co nejdřív po odebrání vzorku. Pak se teprve můžete začít rozhodovat, jestli kombuchou nebo tibi limonádou nebo zázvorovým pivem budete sebe nebo své děti napájet. Pokud informaci z laboratoře nemáte, je lepší přístup better safe than sorry a považovat své šumivé kombuchy za pivo desítku. Nevěřte skálopevným tvrzením, že v domácích limonádách je jen do 0,5 % alkoholu. Rovněž však nelze ani tvrdit, že se vždy jedná o nebezpečný alkoholický nápoj — často bývá alkoholu obsaženo opravdu málo a lze jeho koncentraci dalším ředěním nápoje snižovat.
Obava z bublinek CO₂ přecházejících do trávicího systému kojence přes mateřské mléko je naprosto neopodstatněná, k takovým přenosům v našem metabolismu nedochází a kojenecké koliky jimi způsobovány nejsou (bez ohledu na to, co se tvrdí na internetech).
Pro představu přikládám ty horší případy laboratorního měření alkoholu v kombuchách, zázvorovkách a tibi limonádách od našich čtenářů, vždy se jednalo o domácí kvašení bez konkrétního záměru vyrobit vyloženě alkoholický nápoj, vyšlo to tak náhodně díky způsobu vedení a použitému substrátu:



Je kombucha vhodná pro diabetiky? Odpovězme si spíše na otázku, co je problémem pro diabetiky obou typů: cukr a alkohol. Pokud bude alkoholu a zbytkového cukru ve vašem hotovém nápoji hodně, nebude pro diabetika vhodným nápojem. Pokud bude nápoj veden tak, aby ve výsledném nápoji bylo alkoholu a cukru málo, pak je možné za průběžného měření glykémie pozorovat, jak komu konkrétně jeho nápoj cvičí s jeho krevním cukrem. Hotový nápoj vykysaný dosucha lze přislazovat nezkvasitelnými cukry a sladidly určenými pro diabetiky.
1. typ (vrozený s inzulínovou terapií): kombuchový nápoj obsahuje kyselinu octovou, která pomáhá během jídla a po jídle upravovat krevní cukr směrem dolů, takže je nutné dávat pozor, aby nedošlo k hypoglykémii buď ve fázi hladu nebo spolu s připíchnutým inzulínem; toto onemocnění je neléčitelné
2. typ (získaný): studie na pacientech s diabetem 2. typu naznačují (jedna a další), že kombuchový nápoj upravuje cukr v krvi po jídle, ale rozhodně není lékem, který by toto onemocnění řešil. Tito pacienti hypoglykémií ohrožení nejsou, ale zároveň by svůj stav neměli zhoršovat konzumací alkoholu a cukru. Toto onemocnění je často zvratné, k čemuž vede trvale udržitelná změna životního stylu (pohyb a jídelníček).
V obou případech je potřeba si počínat opatrně, řádně a často měřit krevní cukr a nepovažovat kombuchový nápoj za hrozbu ani lék. Neptejte se jiných pacientů, co dělá konzumace s nimi — jejich zkušenosti jsou nepřenosné, často špatně změřené a mylně interpretované!
Je kombucha vhodná při žaludečních vředech (a jakémkoliv dalším onemocnění)? Obsahuje kyselinu octovou, cukr, při použití listů čajovníku nebo cesmíny (maté) i kofein, podle způsobu vedení alkohol a oxid uhličitý. Porovnejte se seznamem substancí vyloučených z vaší diety dle doporučení vašeho lékaře a odpovíte si. Nic není univerzální, ferment dá se vést téměř bezalkoholově, s minimem cukru, bezkofeinově, dá se ředit. Konzultujte s vaším lékařem, při konzumaci buďte opatrní, ovšem lékař vám poradí správně jen tehdy, když problematice rozumí a ferment dobře zná.
A co histaminová intolerance? Máte-li vyloženě diagnostikovanou HIT, budete muset každou potravinu zvlášť prostě zkusit. Histamin při kvašení vzniká a každý jedinec reaguje jinak na různá množství. Určitou úlevu může přinést doplňování enzymu diaminoxidázy (DAO) ve formě tablet dle příbalového letáku, ale přípravek je drahý a nevyplatí se s ním kompenzovat potíže, které by mohla HIT při pití kombuchového nápoje způsobovat.
Kam se ztrácí cukr? Při každé fermentaci je cukr palivem pro mikroorganismy, přeměňují ho na jednodušší, pro člověka méně kalorické či zcela nekalorické látky — kyseliny, plyny, alkoholy aj. Velký počet napěstovaných mikroorganismů spotřebuje v teple cukr za kratší čas. Slabá kultura v chladu bude spotřebovávat cukr podstatně déle. Přesný čas nelze stanovit univerzálně, v každé domácnosti je kultura v úplně jiném stavu a má úplně jiný výkon při spalování cukrů. Orientujte se podle chuti. Velmi rychlé a účinné ve spotřebovávání cukrů jsou alkoholové kvasinky, což ústí v suchost, perlivost a alkoholovitost. Octové bakterie ho spotřebovávají pomaleji, to ústí v kyselost nápoje.
Jak se zjistí zbytkový cukr v nápoji? Může napovědět jednoduchý hustoměr, jehož měření bude ale ovlivněno i jinými látkami v roztoku. Jinou metodou měření je použití refraktometru, který pracuje na principu lomu světla, ale i ten bude průběhem fermentace silně ovlivněn dalšími látkami v roztoku a hodí se jen na měření počáteční cukernatosti, kterou ale snadno odvodíte od množství cukru sypaného do čaje při zakládání nové várky. V domácnosti je měření vždy jen orientační.
Jak se zjistí obsah alkoholu? To je velmi složitá disciplína a doma byste toho byli schopní orientačně asi jen destilací. Levný ponorný lihoměr i optický refraktometr nepomohou, jsou kalibrovány výhradně na směs vody s etanolem (nebo jiné, předem známé směsi látek), s kombuchou podají zkreslené výsledky (např. o rozpuštěný cukr a vytvořené kyseliny). Jestliže vás tato problematika zajímá, musíte si nechat váš konkrétní ferment zkontrolovat v laboratoři, která zkoušku komerčně nabízí. Zkoušku je nutné provést co nejdříve po odebrání, aby při skladování vzorku nevznikal alkohol dodatečně a neměli jste naměřenou koncentraci vyšší, než jakou máte doma při pití. Metody stanovení alkoholu v různorodém roztoku jsou popsány na stránce Enolog.cz, přičemž sdružení Kombucha Brewers International uznalo jako nejvhodnější a doporučenou metodu plynovou chromatografii.
Pomůže s měřením dechový alkoholmetr? S tím se nestanovuje obsah alkoholu v nápoji měřený v procentech (%), ale v krvi konzumenta v daný okamžik měřený v promile (‰), pročež je potřeba časový odstup dle návodu a ne do něj funět hned po vypití, což každý dělá a návod to zapovídá. Navíc ty domácí jsou jen hrubě orientační a nereagují na nízké intoxikace.
Jak vést kombuchový ferment tak, aby v něm bylo co nejméně alkoholu? Základem je nepodporovat alkoholové kvasinky v množení, neboť platí rovnice tichý nápoj = málo alkoholu. Především nepřidávejte ovoce a nepořádejte 2. fermentaci v uzavřených láhvích. Buď veďte ferment v krátkých 1 – 2 denních cyklech a upíjejte rovnou z hlavní láhve, anebo nechávejte ferment hodně zkysávat (samozřejmě za průběžného žďuchání do placky, aby nezplesnivěla), alkoholové kvasinky nemají kyselé pH rády. V případě pochyb si nápoj i dále po zkvašení řeďte vodou nebo obyč čajem.
Nemůže vzniknout metanol? Ne takové množství, které by vás ohrozilo na zdraví. Metanol vzniká buď při kvašení ovocných pektinů a následně se koncentruje do nebezpečných hodnot při neodborné destilaci, anebo tehdy, když ovocný kvas při destilaci připálíte. Z domácího piva, vína, saké ani limonád se metanolem otrávit nemůžete, pokud si z toho doma pokoutně a neodborně nepálíte kořalku (zdroj).
Pojí se s konzumací nějaká závažná zdravotní rizika? Prý došlo i k otravám! Obecně je kombuchový nápoj při zachování běžné výrobní čistoty a použití nezávadných surovin vzhledem ke své kyselosti dosti bezpečný a různá vágní doporučení nejsou postavená na žádných relevantních statistikách ani četnosti výskytu závažných případů. Pokud budete číst nějaký popsaný případ hospitalizace s hepatotoxicitou či laktickou acidózou po požití kombuchy, všimněte si, že v závěru snad nikdy není prohlášen nápoj jako jednoznačná příčina kvůli zjištěným metabolitům či patogenům. Rovněž bývají pacienti dost závažně nemocní a medikovaní (diabetes, HIV, srdeční arytmie aj.), anebo kombuchy třeba dlouhodobě pili obrovská množství v kombinaci s alkoholem. Jedná se o jednotky případů. Domácí nápoj denně pijí milióny spotřebitelů bez potíží.
Naleptává kombucha zubní sklovinu? O nic víc nebo míň než jiné kyselé potraviny a nápoje. Záleží na úrovni prokysání (obsahu kyseliny octové/glukonové/mléčné) a na stavu vašich zubů. Běžně zdravý a udržovaný chrup tím netrpí, kdo má predispozice, ten si může po napití vypláchnout ústa čistou vodou. Důležité je nepoužít bezprostředně po konzumaci kyselé potraviny zubní kartáček, kterým byste si změklou sklovinu mohli systematicky mechanicky poškozovat. Vypláchnutí v případě nápojů úplně stačí. Řiďte se obecnými pokyny vašeho zubaře nebo ortodontisty. Je zbytečné se kvůli této obavě plošně vyhýbat kysaným výrobkům, ať už všem nebo některým konkrétním.
Tloustne se po kombuše? Nebo se po ní hubne? Ani jedno nelze říci. Tělesná hmotnost se odvíjí od životního stylu, čili od množství přijaté a vydané energie, kvality odpočinku, způsobu stravování, množství stresu, trochu i genetických dispozic a od stavu vlastního jedinečného mikrobiomu a jeho metabolismu. Kombucha s tím nemá mnoho (snad vůbec nic) přímo společného. Nutno přihlédnout alespoň ke zbytkovému cukru — je jasné, že když budete soustavně a ve velkém množství pít sladolep, budete konzumovat hodně okamžité energie. Ze suchého nápoje ani neztloustnete ani nezhubnete.
Kolik můžu kombuchy vypít? Na tuto otázku vám nikdo nemůže odpovědět přesně, je to na vašem rozhodnutí. Žádné spodní ani horní hranice neplatí a pokud o nich někde čtete, jsou zcela vymyšlené. Nutno přihlédnout ke vznikajícímu alkoholu, zbytkovému cukru a nakonec i k individuální snášenlivosti hromadného přísunu mikroorganismů a jejich metabolitů do vašeho trávicího traktu. Prostě zkoušejte.
Má se při užívání dělat pauza? Kombuchový nápoj není stejně jako pivo, jogurt nebo mrkev žádné terapeutikum, které univerzálně vede k nějakému léčení nebo nějaké prevenci — je to jen chiméra, kterou nám prodávají výrobci nebo si ji spotřebitelé moc přejí. Kde není lék, není ani terapeutické dávkování. Kde není dávkování, tam není ani pauza. Všechny pokusy o stanovení obecných terapeutických postupů (denní doba, intervaly, množství) jsou úplnou ztrátou času. Sledujte reakce svého složitého organismu a sobě konzumaci přizpůsobte. Vysledované reakce a osobní úprava konzumace jsou nepřenosné na někoho dalšího.
Zhoršuje nebo zlepšuje pití kombuchy atopický ekzém? Vyrážku? Akné? Chronický střevní zánět? Vaginózy? Zažívání? Nadýmání? Únavu? Neexistuje jednoznačná odpověď. Každý jedinec má jiné potíže, tyto potíže mají diametrálně jiné příčiny, každý pije jiné množství kombuchy v jiný čas, s jiným složením, každý má jiný životní styl, jiné stravovací návyky, jiné množství stresu, kvalitu odpočinku, jiné mikrobiomy různých tělesných nik. Zhoršuje pití kombuchy projevy vašeho onemocnění vám? Pak je to vaše zkušenost a podle toho se zařiďte — uberte na konzumovaném množství, veďte ferment jinak, vysaďte. Zlepšuje vám něco? Pak to zlepšuje jen vám a nemusí to platit pro kohokoliv jiného ve vašem okolí a kombuchový nápoj proto nelze plošně ordinovat, doporučovat nebo od něj zrazovat. A nezapomínejte: ne všechny tělesné projevy, které na sobě pozorujete, jsou nutně způsobeny pitím nebo nepitím kombuchového nápoje.
Jaké účinky pozorují konzumenti? Konzumenti prohlašují úplně všechny myslitelné pozitivní i negativní účinky, na které si vy sami vzpomenete, ale bez měření jakýchkoliv markerů a hodnot prostě nelze jednoznačně prohlásit, že pozorovaný efekt má přímou souvislost s konzumací jedné potraviny (v našem případě kombuchového nápoje). Může se jednat také o komplexnější změnu jídelníčku, spánku, stresové kompenzace, duševního rozpoložení, jiným ročním nebo životním obdobím, přáním. Každý se chce podělit, každý chce přisadit do statistiky. Z osobního pohledu je však bohužel příspěvek do jakékoliv statistiky vždy neplatný, kauzalita absolutně není zaručena a bez kontrolní placebo skupiny se prostě vždy může jednat o placebo či nocebo efekt. Nebo také ne. Ale spíš ano.
Jako protiváhu domnělých pozitivních účinků jsme ve skupině uspořádali anketu o tom, s jakými potížemi průběžná konzumace nápoje respondentům (877 k 12. květnu 2025) nepomohla:
- 30× nepomáhá mi s vysokým krevním tlakem
- 20× nepomáhá mi s rekurentními vaginózami
- 19× nepomáhá řešit opakované záněty močového měchýře
- 19× nepomáhá mi s chronickými střevními záněty (IBD, Crohn)
- 47× nepomáhá mi s každoročními sezónními virózami a rýmami
- 1× piju kombuchu a dozvěděl jsem se onkologickou diagnózu
- 40× nezbavila mne alergie
- 13× nezbavila mne lupénky
- 2× nezbavila mne roztroušené sklerózy
- 25× nezbavila mne atopického ekzému
- 8× i při její konzumaci trpím chudokrevností
- 139× upřímně — pořád mám kila navíc
- 8× nezbavila mne srdečních a cévních chorob
- 74× cítím často únavu
- 26× nezbavila mne migrén a bolení hlavy
- 64× nezbavila mne plynatosti a střevních dyskomfortů
- 89× nezlepšil se mi zrak
- 30× nezlepšila mi sexuální výkonnost
- 4× nezbavila mne podváhy
- 82× nezbavila mne chuti na další kombuchu
- 22× nezbavila mne chuti na alkohol
- 11× nesnížila cholesterol
- 8× nezbavila mne nízkého krevního tlaku
- 1× nepomohla s bolestmi v bedrech
- 31× nedělá nic a dělá to dobře
Jsou vůbec nějaké potvrzené zdravotní účinky? Bohužel stále se hledá a stále nic zajímavého. Už bylo uspořádáno nepřeberné množství studií, ale mnoho z nich je jen teoretických a laboratorních in vitro, nebo na zvířatech nebo sice humánních, ale na malých vzorcích účastníků a bez potřebných kontrolních skupin či s diametrálně rozdílnými výsledky studii od studie. Aktuální a skutečně hodnotné vědecké poznatky jsou shrnovány v takzvaných metaanalýzách, ve kterých odborníci na sestavování metaanalýz vyhodnocují a revidují poznatky z existujících vědeckých článků na dané téma. Několik dost čerstvých jsem pro vás interpretoval v článku Probiotický elixír zdraví 2(025). Můžete se dokonce ptát i ChatGPT a ten bude v těchto otázkách mnohem příčetnější než amatérští chovatelé, alternativní léčitelé, naturopati či prodejci.
Někteří chovatelé sdílí zkušenost, že jim pití nápoje ulevuje od některých typů akutních střevních potíží, pozorují tonizační efekt, což patrně možné je, ale nelze to prohlásit za univerzální pravidlo. Pocitově reaguje nemálo konzumentů zase úplně naopak, zbylí nereagují vůbec nijak nad rámec placebo efektu.
Jestli je na kombuchovém nápoji něco skutečně přínosného, pak jsou to čajové flavonoidy s antioxidačním potenciálem. Ty v nápoji zůstávají a jsou pro člověka velmi přínosné, jenže to není zásluha kombuchy, ale čaje.
U žádných typických produktů kombuchové fermentace/oxidace, jejichž míra zastoupení je náhodná, nebyl popsán zvláštnější dopad na lidské zdraví, než u složek jiných potravin. Kyseliny octová, glukonová, glukuronová, mléčná, vitamíny a alkoholy sice mohou nějaké efekty mít, ale ne o mnoho důležitější, než jiné látky v jiných potravinách. Všechny potraviny jsou svým způsobem funkční a pestrost je silnější než účinek jednotlivých látek či přítomnost jednotlivých mikrobů.
Když je kombuchový nápoj živý, je probiotický? S velkou pravděpodobností ne. Problematika probiotičnosti je velmi složitá a pokud vědci zkoumají probiotický efekt nějakého mikroorganismu na nějakou velmi úzce specifikovanou problematiku lidského těla, tak nezkoumají nic tak širokého, jako celé společenství (kombucha), ani celý rod (třeba kvasinka Saccharomyces), nezkoumají dokonce ani nic tak širokého, jako druh (Saccharomyces boulardii), ale zkoumají něco tak podrobného, jako je kmen (Saccharomyces boulardii GG nebo Lactobacillus rhamnosus HN001). Jelikož váš domácí ferment obsahuje víceméně náhodné složení rodů, druhů a kmenů mikroorganismů, kdy žádné není napříč domácnostmi stejné, jsou náhodné i potenciální probiotické efekty a produkovaná postbiotika. Situace komplikovanější o fakt, že většina organismů žijící ve vaší láhvi není schopna přežít ve vašem trávicím ústrojí a tudíž tam nějak působit. Aby výrobci kombuchu i přes tato úskalí k probiotičnosti donutili, přidávají do hotových a stabilizovaných nápojů probiotické organismy (nejčastěji Bacillus coagulans nějakého kmene), které však nijak ani s kombuchovou fermentací nesouvisí, ani u nich nemusí být prokázán jakýkoliv probiotický účinek pro člověka, neboť se nejedná o lék, ale jen o doplněk stravy. Celý zobecněný koncept probiotičnosti kombuchového nápoje je kolosálně nepochopený, nereálně nadhodnocený a i přesto mohutně poptávaný a stále ochotně slibovaný.
Proč bych měl tedy vlastně kombuchu pít, když říkáte, že je zdravotně k ničemu? To si musíte zodpovědět sami. Není přeci nic špatného na pití nápoje kvůli žízni, chuti a levné domácí výrobě. Kdo ji chce pít jako lék nebo prevenci, je to v pořádku, ať tak činí, když bude smířený s eventualitou, že to na jeho potíže nezafunguje nebo že v budoucnu stejně něčím onemocní. Uvědomme si, že drtivá většina slibovaných účinků jsou spíš přání z doby před sto lety, kdy ještě nebyly vyzkoumány skutečně účinné léky a naturopatie začala být sexy. Často jde o mýty posilované nepodloženými anekdotickými důkazy a o povýšení slova „může“ na jistotu. Rádi se toho dopouštějí jak výrobci, kteří něco potřebují prodat, tak i spotřebitelé, kteří by si přáli jednoduchá řešení na své složité problémy.
Vzhled, péče, slizy, křís a plíseň
Mám kombuchu omývat vodou, aby byla čistá? Ne, je to kontraproduktivní. Asi chcete z celulózy odmýt špínu, aby byla zdravá a krásná, ale celulózový disk je jen kus ubrousku, do kterého se patogeny nepustí, když bude kyselý a promořený bakteriemi kombuchového společenství. Omývání vodou zmenšuje počty zakyselujících octových bakterií a zvyšuje pH na povrchu směrem k neutrálním hodnotám. Neomývat vodou! Stačí nevzhledné kousky otrhat nebo opláchnout v hotovém nápoji. Je možné, že ji někdo vodou omývá a potíže nemá, ale k tomu je potřeba dodržovat o to pečlivěji správné chovné techniky, které když se nedodržují, tak je celulóza náchylnější k plesnivění. Váš ferment má být nevzhledný, kyselý, plný vašich octových bakterií a neumytý. To ho chrání.
Jak to ale dělají ti, co mají tak čisté a hezké placky, ta moje je ušmudlaná, ale stále funguje? Nezkazila se? Placky, které vidíte vyfocené v inzerci, jsou postavené od bakterií na jeden zátah a s minimem výměn čaje, takže se nestihly začít rozpadat, trhat a obarvovat od čajových taninů. Na vzhledu celulózy vůbec nezáleží, protože celulóza ve fermentu vůbec nic nedělá a každá se začne dříve nebo později rozsypávat a obarvovat. Bakteriální celulóza je v momentě vzniku mléčně bílá, v černém čaji se obarvuje intenzivněji dohněda, v zeleném zůstává světlejší, v ibišku se červená. Není na tom nic pozoruhodného a záviděníhodného, čeho byste měli chtít dosáhnout, starší a nevzhlednější neznamená horší, různé barvy neznamenají různé druhy ani různé kvality.
Mám v nápoji sraženinu. Nebo nějaký chuchvalec. Trošku takového hnědého slizu. Pění to. Vadí to? Ne, to všechno je normální. Až budete slévat, tak to můžete odcedit, jinak to není potřeba řešit. Kdybychom chtěli svoje jídlo čisté, bez slizů a chuchvalců, tak doma nefermentujeme. Vše, co není mazlavý, bílý povrchový křís nebo vláknitá, povrchová a vykvetlá plíseň, je povoleno.
U dna je něco špinavého, takové hnědé/zelené blátíčko, co to je? Mrtvá těla kvasinek s bylinným sedimentem a rozpadající se celulózou. Nic na závadu. Občas to vylijte.
Kterou stranou má být vložena celulóza do láhve? Je to jedno, ale většinou nahoře se ponechávají čerstvé světlé přístavky a dole se otrhávají rozpadající se třásnité fragmenty. Jde jen o kosmetickou záležitost.
V celulóze je díra. Vadí to? Absolutně to nevadí. Bakterie ji stavbou za nějakou dobu zacelí.
Nápoj zhoustl jako sirup, co to je? Běžná vada sladkých fermentů, ve kterých se rozmnožila bakterie Leuconostoc nebo Pediococcus. Není to nebezpečné, jen se to pak nikomu nechce pít. Zpravidla po několika opakováních odezní a už se neopakuje. Zkuste ubrat na cukru (třeba jen 5 % na vstupu) a prokysat nápoj hodně do kysela. Kdyby to nepomohlo a hustý viskózní výsledek se dostavoval opakovaně, sežeňte jinou kulturu.
Silný čajový výluh se po zchlazení a vložení kultury brzy zakalil a je teď mlhavě neprůhledný, co to je? Je to běžná vlastnost rozpuštěných taninů ve vodě, efekt je ještě silnější, když je voda tvrdá (s vápníkovými ionty) a když vychladne. Nálev se zase pročistí, když klesne pH vlivem produkovaných kyselin (podobně jako když do kalného šálku čaje přidáte citrónovou šťávu). Není potřeba to řešit a s kombuchou cokoliv dělat.
Pokud jste si jistí, že nejde o tvrdou vodu ani příliš silný výluh, tak mléčné bílé zakalení způsobují i laktobacily, známý efekt z tibi limonád. Ani to není na závadu.
Na hladině se udělal křís, proč? Křís je matná, bílá, souvislá či ostrůvkovitá vrstvička kvasinek, která se při dotyku rozpadne a nalepí na stěny sklenice. Někdy je i silnější a tvoří tlustou zvlněnou mázdru. Utvoří se tehdy, když necháte bez povšimnutí cokoliv sladkého stát na vzduchu příliš dlouhou dobu a bakterie nestihnou zakysat obsah, což je v drtivé většině způsobeno slabou kulturou s malými počty mikroorganismů. Křís není na závadu, neprodukuje jedy, jsou to jen neškodné kvasinky, ale značí slabý a pomalu fermentující nálev. Je potřeba pracovat s kulturou tak, aby byla silná a do sladkého čaje přidávat nejen neplovoucí placku, ale i 10 % a více aktivního zákvasu z minula, aby byl nápoj hotový dříve a nestihl se na povrchu pokazit. Nemáte-li zákvas, vyrobte si ho tak, že celulózovou placku dáte na den či dva do malého množství čaje (zhruba jen trojnásobného, jako je váha placky) a když prokysá, startujte s ním další várky.
Abyste se křísu zbavili, chce to trochu zkušeností. Ano, lze vzít placku a trochu nezasaženého zákvasu staženého třeba hadičkou ze dna a zkusit to znovu, ale křís se často vrací, zvláště do slabých kultur vedených s příliš dlouhými cykly. Když si seženete rozjetou aktivní kulturu a budete ji vést s kratšími cykly a poměry dle kalkulačky, bude vám nápoj prokysávat tak rychle, že nestihne zkřísovatět.
Následují typické křísové situace:




Placka na povrchu zplesnivěla, proč? K rozvoji plísní na potravinách dochází kvůli souběhu několika jednoduchých podmínek:
- substrát je vlhký a obsahuje cukr (čaj pro kombuchu to splňuje)
- substrát je v kontaktu s kyslíkem (hladina čaje či placka plovoucí na hladině)
- spory plísní o velikosti jednotek μm poletují ve vzduchu a dosedají na sebelépe uvařený sladký čaj v sebelépe vysterilizované sklenici v následujících dnech i přes ubrousek nebo plátýnko,
- spory vyklíčí a houbové mycelium se rozbují na hladině nebo na celulóze tehdy, když není dost nízké pH substrátu či jeho povrchu (slabá kombuchová kultura, málo zákvasu),
- povrchové patogenní organismy bují, když je nikdo nevyrušuje a vy necháváte kombuchovou sklenici stát 5 – 14 dní přikrytou ubrouskem a čekáte… (na co vlastně čekáte?)
Z toho vyplývá ochrana kombuchy před plísní: mít silnou kulturu, používat dostatek zákvasu z minula, správný poměr surovin dle kalkulačky a nenechávat postávat ferment s plackou absurdně dlouho na volném vzduchu. Nikdy vám nezplesniví, když budete cyklus opakovat každé dva tři dny. Potřebujete-li kysat déle, štouchněte aspoň obden do placky na hladině, ať se přes ni přelije vlna a neoschne. Nestihne-li nálev zakysat na příjemnou chuť ani za týden, máte slabou kulturu nebo nesprávné poměry čaje, zákvasu a celulózy (viz kalkulačka).
Určitý vliv na nežádoucí plesnivění vašich fermentů může mít fakt, že ve vaší domácnosti či prostorách, kde máte otevřenou láhev s kombuchou, je silná koncentrace plísní třeba z neřešeného plesnivého zdiva vlhké stavby.
Naopak zcela mizivý vliv na rozvoj plísní má čistota nádobí a náčiní, sahání na placku rukama, vstupní suroviny (čaj, cukr) nebo dokonce fáze Měsíce. To všechno snadno zvládnete přetlačit silnou kulturou a jejím správným vedením.
Pokud je placka pod hladinou a na hladině se objeví pár bílých, chlupatých, barevně nevykvetlých a kulatých ostrůvků plísně, můžete ostrůvky vyhodit, celulózu vytáhnout a spolu s trochou nezasaženého zákvasu použít na další várky. Veďte cykly v kratších intervalech a s poměry surovin podle kalkulačky.
Pokud je pár chlupatých, kulatých, nevykvetlých ostrůvků vrostlých do celulózy, můžete zasažené vrstvy odloupnout a vyhodit a zbytek kultury použít na další várku.
Pokud se plíseň silněji rozrostla a utvořila už barevné spory, bude těžké se kontaminace zbavovat a nestojí to za to: sežeňte novou rozjetou kulturu od domácích chovatelů a veďte ji v kratších intervalech s poměry surovin podle kalkulačky.
Následují typické plísňové situace, všimněte si, že kolonie jsou vždy suché, vláknité a nejčastěji kruhaté:






Jak poznám sraženiny, celulózu, sliz, křís nebo plíseň?
- Sraženiny a pěny jsou prostě shluky bublinek, buď bílých nebo obarvených od čaje, různé šlemy, mlhy a cáry pod hladinou i na hladině. Mohou se tvořit už během několika hodin kvašení a jsou neškodné.
- Celulóza je zpočátku průhledná, lesklá, pružná, souvislá slizovitá vrstva na hladině, která tloustne přístavbami od bakterií, s přibývající hmotou je neprůhledně mléčná a tuhá jako želatina nebo kůže, postupně se špiní od čaje, kolem ní se shlukují různé neškodné slizy a čajové sraženiny. Může být hladká nebo hrbolatá, od vlhkosti a nápoje má být mokrá a lesklá. Bakterie ji v dostatečně silné kultuře začnou stavět během jednotek dnů a je to ten útvar, který si mezi sebou lidé předávají a říkají mu nesprávně ‚houba‘.
- Křís je matná, bílá, souvislá či ostrůvkovitě potrhaná vrstvička různorodých jednobuněčných aerobních kvasinek, která se při dotyku rozpadne a nalepí na prsty, nádobí a stěny sklenice. Někdy je i silnější a tvoří tlustou zvlněnou mázdru a může pokrývat i vrstvu celulózy. Netvoří viditelná vlákna. Tvoří se během jednotek dnů (zhruba 3 a více), když je hladina v kontaktu se vzduchem, kultura slabá a nestíhá čaj zakysat.
- Plíseň je souhrnné označení pro tisíce druhů vícebuněčných hub, které mají podobu viditelných vláken (hyfy, mycelium) rostoucích v kruzích či pokrývající už celý povrch. Vyrůstají během jednotek dnů (zhruba 4 a více) a dříve nebo později tvoří mikroskopické plodnice s barevnými sporami. V případě kombuchy se plísně objevují buď přímo na nezakysané hladině bez celulózy, anebo výhradně na té straně celulózy, kde je kontakt s kyslíkem. Nikdy pod hladinou.
Zde galerie s popisky uvnitř:





















Chov
Koupil jsem si v bioobchodu násadu ve skleničce, podle návodu dal do 1 litru sladkého čaje, čekal dva týdny a nálev nic nedělá, placka neroste nebo to zplesnivělo. Proč? Protože ty kultury prodávané v obchodech mají příliš dlouhý distribuční čas a než se k vám dostanou, vymřou počty a druhy mikrobů v nálevu. Druhou potíží je, že přiložený návod je skoro vždycky špatný, navádí vlít kulturu do příliš velkého množství čaje, čímž kulturu naředíte a ta pak nefermentuje a neoxiduje účinně. Je mnohem lepší si sehnat odnož od někoho, kdo chová doma aktivně a pracovat aspoň v začátcích dle kombuchové kalkulačky a našeho začátečnického návodu.
Dá se vypěstovat z koupené limonády? Záleží na tom, jakým způsobem byl prodávaný nápoj vyrobený a jestli obsahuje dostatečnou koncentraci bakterií, které dělají kombuchu kombuchou (octových Komagataeibacter a dalších). Nebude to fungovat, pokud byl nápoj technologicky významně naředěn ochucujícími složkami nebo pokud byl nějak mikrobiálně stabilizovaný (pasterizací, filtrací). U nápojů, které deklarují speciální probiotické mikrobiální složení (Lactobacillus coagulans, Saccharomyces boulardii, Bifidobacterium lactis), se vám pravděpodobně toto unikátní složení nepodaří chovem udržovat, protože bylo dodávané do výrobku až po dokončení fermentace a je ve vašich domácích podmínkách nekultivovatelné. Zůstanou možná jen běžné kombuchové kmeny a z nich po pár opakováních obyčejná kombucha. Mnohem spolehlivější rozjezd zajistí placka a dobře promořený nálev od domácího chovatele.
Když mi vyrostlo něco podobného na octu, je to taky kombucha? Ocet osídlený celulózotvornými octovými bakteriemi i kombuchová limonáda sdílejí stejné nebo podobné octové bakterie, které umí produkovat kyselinu octovou a celulózu. Držíte-li v ruce celulózu, máte docela dobrou šanci, že ji upletl Komagataeibacter xylinus — stejná bakterie, jako ta, kterou si lidé chovají v kombuchovém společenství. Kombucha není jen Komagataeibacter, jsou to další různorodé octové bakterie Acetobacter nebo Gluconobacter, někdy i laktobacily a spousta dalších náhodně kolemjdoucích, svou roli tam hrají různé houby — kvasinky. Ty se ale dají do společenství přidat z běžného životního prostředí.
Najdete-li celulózovou placku v obyčejném octu, pak máte kombuchový bakteriální pilíř, který lze transplantovat do čaje a svou kulturu si vytvořit. My jsme to provedli a máme o tom článek Vypěstoval jsem kombuchu z ničeho.
Dá se vypěstovat kombucha od začátku na čaji bez startovací kultury? Určitě ne tak, jak by si mohl začátečník představit: že vystaví sladký čaj na vzduch a počká. Hladinu velmi brzy poroste aerobní křís nebo rovnou plíseň a ne žádná celulóza. Je nutné nejdříve octovým postupem přes alkoholický nápoj získat celulózotvorné octové bakterie v dostatečném počtu, ty transplantovat do čaje a za soustavného vedení a opakování k nim pozvat ostatní symbionty. Nemáte-li s chovem octových bakterií a fermentováním obecně zkušenosti a vyvinutý cit, je snazší sehnat si hotovou kulturu od běžného domácího chovatele. Více napoví článek Vypěstoval jsem kombuchu z ničeho a Ocet.
Proč se používá placka i zákvas? Protože placku, která když plave na hladině, vytváří a obývají octové bakterie ve vysokých počtech, je nositelem těchto důležitých organismů, ale je tak kyselá, že v ní nebydlí alkoholové/plynotvorné kvasinky, které se do příštích nálevů přenášejí pomocí nálevu z minula (ten je méně kyselý než placka). Když ale i ten prokysá napadrť, alkoholové kvasinky usnou i v něm. Použití placky i zákvasu dle kalkulačky je nejspolehlivější zlatá střední cesta, kterou lze doporučit začátečníkům a která je nejlepší ochranou proti pokažení, chovatelé tím neudělají chybu. Vynechají-li placku nebo zákvas, může kultura fungovat, ale může dojít snáz k problémům, když nemají chovatelé zkušenosti a neznají souvislosti.
Jak se pozná dobře aktivní kultura? Podle toho, že vykazuje změny chuti v uplynulém čase. Když ji naložíte dle návodu či kalkulačky do sladkého čaje, měl by se tento sladký substrát v průběhu příštích asi tří dnů (méně než týdne) vlivem bakteriální aktivity zakyselovat až do té míry, která je vám příjemná na chuť. Vedlejším efektem je růst celulózové blány a někdy i bublání. Slabá kultura ani za týden nápoj nezakyselí.
Co když bakterie nestaví na hladině placku vůbec? Pokud se vůbec neprojevuje tendence k zakládání celulózového biofilmu na hladině, tak to znamená, že je hustota bakterií v nálevu nedostatečná. Buď vlivem přílišného naředění nebo vymření. Nejjednodušší je sehnat od chovatelů dobře aktivní kulturu. Neházejte ale kulturu do žita předčasně, nejdříve zkuste otázku „Jak si vypěstuji z malé placky velkou?“.
Jak mám obnovit výrobu limonády, když byla kultura týdny, měsíce či roky uklizená a je teď hodně kyselá? Pár cyklů proveďte zhruba v polovičním množství čaje a s polovičním množstvím zákvasu, než v jakém byste chystali podle kalkulačky standardní várky. Jen počítejte s tím že vysoká koncentrace kyselin bude způsobovat ještě několik várek kyselý nápoj, vypodkládejte placku v primární láhvi kousky ovoce, abyste zase vrátili do nálevu život, který při čekání usnul nebo vymizel. Stále platí, že máte nálev od nultého dne obnoveného cyklování průběžně ochutnávat.
Jak se pozná stará placka? Kdy je už opotřebovaná a na vyhození? Placka nestárne, nemá životní cyklus, je to celulóza. Bakterie ji přistavují ve vrstvách na té straně, kde je v kontaktu s kyslíkem, celulóza se v kyselém prostředí zase samovolně rozpadá a bakterie ji zase rozežírají jako zdroj uhlíku. Staré třásně otrhávejte, nové vrstvy nechte vznikat. Nikdy ji není potřeba kompletně zahodit a začít znovu. Sama o sobě nemá žádnou funkci, je to jen dům pro mikroorganismy.
Co je to kombuchová dcera? To samé, co původní placka — kus celulózy, kterou uštrikovaly na hladině za přístupu kyslíku octové bakterie. Nemá jinou hodnotu, nenarodila se, není to nová generace, není produktem placky.
Při jakých teplotách F1? Při jakých teplotách F2? Nejdřív v teple a pak do zimy? Nebo jak? Mám v tom zmatek! Teploty nijak pečlivě řešit nemusíte. Každou fázi kvašení můžete provádět při jakýchkoliv teplotách v rozmezí od 1 °C do 35 °C a vždycky to bude fungovat. V teple (22−26 °C) mikroorganismy pracují rychleji a spíše se prosazuje alkoholová kvasinka, v chladu pracují mikrobi pomaleji. To je celé.
Nevadí, že kombucha zmrzla? Můžu ji mrazit? Nevadí, můžete, celulózová placka nic nedělá a jakékoliv její poškození nemá vliv na funkci, které je zajišťováno okem neviditelným mikrobiálním společenstvím. Bakterie mrazy přežívají, takže kysat bude po rozmrznutí celkem ochotně, nicméně alkoholové kvasinky mráz do velké míry potrhá, takže nápoj bude méně (či nebude vůbec) perlit, dokud kvasinky zase několika běžnými cykly při pokojové nebo mírně zvýšené teplotě (~26 °C) nenamnožíte (viz dotaz na bublání). Pokud se ale rozhodnete placku zmrazit a pak zase použít na start kvašení, nezapomeňte si přimrazit i obligátní množství zákvasu, bez něj to půjde fakt pomalu.
Může být kultura na světle? Ano, nemusíte to řešit, UV záření ferment nezabije. Ozónovou vrstvou prochází jen neškodné záření UV‑A (315 až 400 nm) a UV‑B (280 až 315 nm), kdežto bakteriocidní UV‑C (200 až 280nm) už se k vám do kuchyně přes atmosféru a přes sklo nedostane. Pro dezinfekční účely (např. při úpravě vody) je nutné si na něj pořídit UV lampu a do cesty nestavět sklo.
Smí se v místnosti s chovem kombuchy kouřit nebo topit v kamnech? Ano, kombucha se vám nezkazí, to je vymyšlený mýtus. Dobře nainstalovaná, kvalitní a provozovaná kamna nebo krb by neměly negativně ovlivňovat kvalitu vzduchu v domácnosti do takové míry, aby umíraly houfně mikroorganismy. Kouření v domácnosti je spíš ohavné než cokoliv jiného. Co se týče plesnivění, tak to má příčiny v něčem jiném (viz dotaz na plesnivění).
Jaké láhve se na chov používají? Pro běžnou domácí produkci jsou úplně bezvadné obyčejné 3,5 litrové láhve od zeleniny zdarma, placka v nich má průměr 15 cm. Na pití a dokvášení se slévá pokud možno do běžných PET o objemu 1 – 2 l. Jedná se o nejlevnější, nejpraktičtější a nejbezpečnější sestavu.
Musím láhev vymývat a vyvařovat? Musím pracovat v rukavicích? Nebude ve výpustním kohoutku plíseň? Tyto obavy o hygienu nejsou na místě, pokud máte dobrou aktivní kulturu, která úspěšně a rychle prokysává nápoj. V běžné středoevropské domácnosti máte uklizeno a čisto dostatečně, takže láhev vyvařovat nebo dezinfikovat nemusíte, nemusíte nosit gumové rukavice a bát se zaplísnění výpustního kohoutku. Důvody zaplísnění jsou vysvětleny výše. Kdybyste používali alkoholovou desinfekci, bude denaturovaná hořkým bitrexem a ten, když se nevymyje důkladně, chutná opravdu odporně.
Můžu placku krájet? Ano. Je to kus celulózy. A klidně na to vezměte kovový nůž.
Kov? Kovové předměty přeci kombuchu zabíjí? Ne, nezabíjí. Mýtus vznikl z původního správného doporučení, že se nemá kvasit v nádobách z korozivních materiálů, jako je hliník, měď nebo neošetřený plech, protože bakterie produkují kyseliny a ty jak známo přispívají ke korozivním procesům (nádoba zrezne). Jakmile budete kvasit v nekorozivních materiálech (sklo, potravinářský plast, kvalitní nerez), nic se neděje. Při letmém kontaktu s korozivním materiálem se také nic neděje. Bakterií máte v nálevu bilióny, kontakt s kovem je neumrtvuje. Celulózová placka rovněž nemůže utrpět žádnou újmu na zdraví, protože žádné zdraví coby celulózová placka nemá. Je to stejné, jako byste se dotkli cedníkem celulózového ubrousku nebo toaleťáku — nestane se vůbec nic.
Nezvětšuje se, neroste, jen se vznáší v čaji, proč? Vaše celulózová placka není organismus, který by nějak přirůstal vlastním přičiněním, tloustl a rostl jako rostlina nebo houba. Bakterie octového kvašení, které se nacházejí v nálevu i v placce, přistavují celulózové vrstvy jen tam, kde je kontakt s kyslíkem, čili na hladině. Ponořená celulóza se nikdy nezvětšuje a není důvod se tím znepokojovat.
Neplave, asi je mrtvá. Proč? Celulózový koláček nemůže být mrtvý, protože nikdy nebyl a není živý. Pokud se jen vznáší uprostřed substrátu nebo leží u dna, tak to znamená, že kvasinky v nálevu neprodukují dost plynu, který by se ve vrstvách celulózy v průběhu přistavování zachytával a tudíž není celulóza nadnášena. To se týká především těch placek, které jste si přinesli od někoho: jsou potrhané, jsou tenké, jsou z nich vymačkané bubliny a nezabírají celý průměr vaší láhve tak, jako u původního chovatele. Pokud se vám to nějak podaří, zkuste pod placku umístit pár kousků jakéhokoliv ovoce nebo ovocných slupek. Ovoce začne alkoholově kvasit, vznikající CO₂ ho bude nadnášet a pak bude mít i tendenci vynášet placku na hladinu. Na hladině budou bakterie stavět nové vrstvy. Prokvašené ovocné bójky při slévání nápoje vyměňujte, jezte nebo vyhazujte.
Nevadí, že placka není celá ponořená a plave na hladině? Nevadí. Plavání na hladině je preferovaný stav.

Placka mi šplhá do hrdla láhve. To chce jako utéct? Produkovaný oxid uhličitý z nápoje ji vytlačil do zúžení hrdla. Neplňte láhev tak doplna. Šťouchněte placku zpátky a pokračujte.
Jak si vypěstuji z malé placky velkou? Máte-li už pár várek s malou plackou vyzkoušených, máte jistotu, že nápoj prokysává dostatečně rychle a chcete přejít na větší láhev, netopte placku o velikosti dlaně hned ve 3,5 litrech čaje, to by bylo příliš málo bakterií na neadekvátně velké množství substrátu. Postupujte takto:
- Se svou malou plackou si přichystejte asi litr dobře prokysaného nápoje (nemusí to být vyloženě ocet, stačí pitelná solidní kyselost), to bude váš zákvas
- do větší sklenice (např. klasické okurkové s objemem 3,5 litru) vlijte půl litru zákvasu, dobře ho oslaďte obyčejným cukrem, protože bakterie budou stavět celulózu z glukózy, vložte na dno malou placku a láhev neprodyšně uzavřete víčkem nebo fresh fólií s gumičkou, aby ke kultuře neproudil volně vzduch se sporami plísní — to bývá při delších stáních jakéhokoliv fermentu zdrojem zaplísnění; sklenici umístěte kamkoliv v bytě, kde je běžná pokojová teplota 20 – 25 °C
- zbylý půllitr zákvasu uložte v PET láhvi do lednice
- počkejte dva týdny, až ve sklenici bakterie kolem malé celulózy postaví ze zákvasu větší silnou placku po celé hladině
- máte-li velkou placku postavenou, přilijte půllitr uschovaného zákvasu z lednice a 1 – 2 litry čerstvě uvařeného oslazeného čaje a dál už pokračujte v běžných cyklech ve vaší nové 3,5 litrové láhvi překryté jen zagumičkovaným ubrouskem s poměry ověřenými v kombuchové kalkulačce; aby nově postavená placka plavala na hladině, strkejte pod ni pár kousků ovoce, které ji bude při alkoholovém kvašení nadnášet, octové bakterie pak budou shora přistavovat nové vrstvy.
Je poněkud bezpečnější mít při delších stáních láhev takto zavřenou a nenechat do ní volně proudit vzduch: octové bakterie si vystačí pro stavbu celulózy s kyslíkem ze vzduchové kapsy i několik týdnů. Kdybyste čekali týden či dva na růst celulózové placky na proudícím vzduchu pod ubrouskem, bude vzduch přinášet na hladinu všudypřítomné spory plísní a povrch může zplesnivět. Věčným čekatelům se to stává často.

Když jedu pryč na dovolenou, co mám s kombuchou dělat? Naložte celulózovou placku do zhruba dvojnásobného množství sladkého čaje (když váží 250 g, naložte do 500 g čaje), uzavřete do krabičky nebo sklenice takového objemu, aby byla plná (v tomto případě 3/4 litrovka) a vložte do ledničky. Proč se nádoba uzavírá? Aby dovnitř na hladinu a na placku neproudil volně vzduch přinášející spory plísní a nechtěných aerobních křísových kvasinek. Neberte v potaz neplatnou poučku, že placka potřebuje vzduch. Placka nepotřebuje nic, nežije. Octové bakterie, které chováte, přežijí s minimem kyslíku v pohodě měsíce až roky.
Po návratu placku neomývejte vodou (!), založte obvyklou várku a prokysaný čaj z lednice použijte jako zákvas. Kysat bude v každém případě, ale chvíli bude trvat, než se do kvašení vrátí i alkoholové kvasinky. Čím delší odpočinek, tím pozvolnější rozbublávání. A ještě poslední odpověď: ne, placka se nezkazí, protože jde o kyselý ferment, u kterého dochází produkcí kyseliny k zabezpečení proti zkažení (hle — zelí, miso, kefír, jogurt — vše nekonečné).
Jak odložit kombuchu na opravdu dlouhou dobu, třeba na rok? Platí stále to, že mikroby musíte krmit průběžně i v chladném prostředí, tj. musíte jim aspoň jednou za čas poskytnout sladký čaj. Na placku ohledy neberte, už víte, že je to jen netečná neživá placka. Je pravděpodobné, že čím déle bude spolek organismů s nálevem uložen v chladu a třeba i ponecháván déle bez krmení, tím bude větší pravděpodobnost, že se bude chovat po revitalizaci v teple víc jinak, než před uložením do ledničky a jeho uvedení do původního stavu bude vyžadovat více opakování krmících cyklů. Je možné, že kultura bude tak lenivá, že bude snazší si obstarat dobře rozjetou odjinud.
Má se přidávat pro jistotu ocet? Ne, ocet nepotřebujete přidávat, stačí použít zákvas/nápoj z minula, který kyselinu octovou obsahuje. Pokud ho nemáte a přinesli jste si placku od někoho jiného, umístěte placku do malého množství sladkého čaje a tak si zákvas za den či dva sami připravíte. Pak už můžete adekvátně množství substrátu navýšit podle zdejší kalkulačky. Pokud je kultura slabá a nesprávně ji povedete, přidávaný ocet na tom mnoho nezlepší.
Jak řešíte mušky v podzimním období? Neřešíme, máme obyčejné zavařovací láhve se zúženým hrdlem, na kterých je gumičkou připevněný látkový nebo papírový ubrousek. Žádná věda.
Do láhve mi vletěly mušky octomilky a po povrchu celulózy chodí červíci, co teď? Ve skutečnosti se nejedná o červíky, ale larvy, nicméně nejsou nijak nebezpečné, devastující ani odporně špinavé. Larvičky odmyjte pryč nálevem (ne čistou vodou) a pokračujte v běžném provozu. Na vypité larvíky octomilek ještě nikdo nikdy neumřel. Na strach ano.
Co mám dělat s přebytečnou celulózou? Je mi jí líto vyhazovat. Dá se sníst? Celulóza je bezcenná, opravdu to není živý organismus, kterého by vám muselo být líto. Lze kandovat v cukru jako bonbóny nebo vytvářet ovocnou sušenou kůži na mlsání. Někdo celulózu vyplachuje od kyselosti v pitné vodě a na proužky nakrájenou ji přidává do vaření, třeba do číny. Celulózu nedokáže člověk strávit, ale může posloužit jako nízkokalorický sytič, některým mikroorganismům tlustého střeva může posloužit jako potrava (prebiotikum).
Krmení a suroviny
Půjde kvasit s nějakým alternativním sladidlem? Obecně se sladí sacharózou (řepným nebo třtinovým cukrem — panelou), který obsahuje jak jednu molekulu glukózy pro octové bakterie, tak jednu molekulu fruktózy pro alkoholové kvasinky. To je univerzální krmivo, které poskytne energii širokému spektru mikroorganismů, používají ho nejraději. Pokud si hlídáte příjem cukru (viz dotazy na diabetes), slaďte čaj nižším množstvím stolního cukru (třeba 4 %) a po prokvašení na požadovanou chuť doslaďte alternativními nezkvasitelnými cukry, kterým název končí na koncovku ‑ol.
Cukerné alkoholy xylitol, sorbitol, erythritol či mannitol jsou netypické zdroje uhlíku, které umí zpracovat jen některé mikroorganismy. Pokud vím, tak bakterie a kvasinky přítomné v kombuchovém společenství je fermentovat nedokážou a kultura zeslábne, přestane kysat a brzy vám ji přepadne při dlouhém čekání nějaká plíseň.
Steviol ze stévie je glykosid bez energetické hodnoty pro mikroby. Lze s ním ochucovat, ale bakterie a ni kvasinky jej nemohou použít pro svůj život.
Moučkový cukr je obyčejná sacharóza umletá najemno s přídavkem protispékavých látek, jako je škrob nebo fosforečnan vápenatý. Obě látky jsou bezpečné jak pro mikroby, tak pro člověka, obě budou kvůli nerozpustnosti sedimentovat ke dnu. Moučkový cukr lze pro krmení kultury použít.
Med (100 g medu zastoupí jen 82 g cukru) není alternativní sladidlo, nýbrž obyčejná směs zkvasitelné glukózy, fruktózy a sacharózy, stejně jako jiné květové a ovocné cukry: palmový, kokosový, datlový, sladěnka (maltóza), melasa ap. Med nemá tak silné protibakteriální účinky, jak se traduje, kvašení probíhat bude. Agávový sirup bývá směsí běžných cukrů a nerozpustné vlákniny inulinu, čtěte složení. Všechny tyto alternativy tedy nejsou alternativy ke stolnímu cukru, ale většinou velmi drahé cukerné sirupy s menším nebo větším podílem balastních látek či vlákniny. Kombucha s nimi bude fungovat, ale draze.
Inulin přidávat při kvašení lze, je to zkvasitelný polysacharid poskládaný z fruktóz. Při jeho nadměrné konzumaci kvasí v tlustém střevě a dostavuje se plynatost, člověk jej strávit a využít pro sebe nedokáže, mikrobi ano.
Více o cukrech při fermentování vám odhalí článek Cukr.
Mám rozpustit cukr v horkém čaji nebo počkat až vychladne a pak ho tam nasypat? Ano, i na toto se ptáte a je vskutku úplně jedno, kdy, za jakých okolností a jak do substrátu cukr uvedete. Fakt je to jedno.
Může být tvrdost vody problém? Mám to řešit? Zrovna u kombuchové kultury je složení vody zcela zanedbatelným parametrem, není třeba ji řešit, octové bakterie ji ignorují a potíže kvůli vodě nevznikají. Jde jen o to, jak vám nápoj z té které vody chutná, můžete filtrovat, ale nemusíte. Tvrdá voda může způsobovat nevzhledné, leč neškodné zakalení taninů v silných čajových výluzích, viz otázka na zakalení.
Můžu z černého čaje přendat kulturu do zeleného a pak do ibišku a do šípku a do kopřivového nálevu? Smím použít bílý? Můžu to pak zase vrátit? Ano. Vůbec o tom nemusíte přemýšlet jako o problému a otázce, bakteriím je to úplně jedno. Nic tím nepokazíte. Dělejte to zcela libovolně. Neshánějte různé kultury na různé substráty.
Je nutné dopřát kultuře aspoň někdy černý čaj? Není to nutné, bakteriím je jedno, z jakých a jak upravených bylin jim dodáte dusík. Míra oxidace buněčných šťáv čajovníku nehraje roli. Kultura není závislá na ničem konkrétním, potřebuje jen z cukru uhlík a z rostlin minerály a dusík.
Můžou se používat jiné byliny než čaj, třeba rooibos? Je kombucha závislá na kofeinu? Jiné byliny než čajovník čínský se používají běžně. Iluze nutnosti kofeinu vznikla historicky z faktu, že lidé transplantovali běžné octové bakterie do čaje a tak dlouho je v něm chovali, až na původ bakterií zapomněli a usmysleli si, že kofein v čaji je nutnost. Mikrobiální společenství kombuchy je pestré, každý mikrob umí využívat jako zdroj uhlíku a dusíku různé molekuly látky, některé organismy se umí v případě potřeby přepínat. Některé umí využít kofein jako zdroj dusíku a je-li kofeinu/dusíku dostatek, prospívá společenství (zvláště octové bakterie produkující celulózu) lépe. Záleží však samozřejmě na tom, v jakém stavu konkrétní kultura je a zda se vůbec mikrobi do kofeinu pustí, když mají k dispozici jednodušší zdroj dusíku. Znamená to, že kofein (potažmo lístky čajovníku čínského) není životně důležitý, ale je někdy využitelný. Článků na Google Scholar je poměrně dost a lze v nich hledat měření úbytků, které by naznačovalo rozklad kofeinu za účasti mikroorganismů. Cesmína paraguayská (maté) i cascara jsou rovněž zdroje kofeinu a kultura s nimi funguje dobře.
Můžou se používat aromatizované čaje? Kulturu tím nepoškodíte, ale některá aromata jsou tak neodbytná (zvláště lesní plody, broskve), že pak bude kultura s plackou vonět ještě nějakou dobu. Některé molekuly aromatizačních látek se fermentací mohou pozměnit a z vůně se může stát dost nepříjemný zápach. Některé jsou ale moc dobré, třeba bergamot. Pokusy dělejte na odnožích.
Můžu používat sáčkový čaj? Jistě, na typu balení skutečně nesejde. Pokud výrobek deklaruje, že jsou v sáčku byliny nebo čaj a nejsou přidané konzervanty, které by poškozovaly mikrouše (což nebývají, není k tomu důvod), klidně používejte sáčky. Většinou vycházejí porcované čaje nesmyslně draho — v obchodech konzultujte cenu za kilogram. Když se k použití rozhodnete, pak se na obalu podívejte, kolik gramů je v jednom sáčku a podle kombuchové kalkulačky spočítejte potřebný počet vašich sáčků pro vaše chované množství.
Jak dlouho mám nechat čaj louhovat? Častou odpovědí čajomilců je: 3 minuty (podle běžné konvence a návodu na přípravu na obalu). Jenže to by platilo pro přípravu nápoje určeného pro přímou konzumaci. V šálku horkého nápoje jsou taniny (třísloviny) nežádoucí. Jenže kombuchový ferment promění chuťově čajový výluh tak dramaticky a tak moc všechno zakryje octem, že všechny nuance zaniknou a chybí-li třísloviny, je kombuchový nápoj nudný. Nebojte se experimentovat a louhovat třeba i několik hodin! Silné výluhy jsou nejen zdrojem dusíku pro spokojené a vitální mikroorganismy, ale i zdrojem příjemně trpkého vjemu v hotovém nápoji! Pokud vám ale taniny nevyhovují, louhujte jen krátce. Je to na vás.
Můžu přidávat ovoce už do první fermentace do čaje? Jasně, na to se nemusíte nikoho dovolovat. Buďte samostatní a kreativní. Akorát si tím základní kulturu navoníte a když zjistíte, že vám nevyhovuje třeba vůně borůvek nebo zázvoru, bude vám tam ještě nějakou dobu strašit.
Když se na placku nalepí čajové lístky, čajový prach nebo zbytky ovoce, zkazí se mi to? Ne o nic pravděpodobněji než bez nich, zrovna třeba čajové lístky jsou stejná celulóza jako ta, která tvoří kombuchovou placku. K plesnivění dochází z úplně jiných důvodů (viz příslušná kapitola o křísu a plísních).
Jaké přídatné látky můžou kombuchové mikroby poškodit? Mám se bát aromat, koncentrátů, sladidel? Aromata, ovocné koncentráty ani alternativní sladidla kombuchové mikroorganismy přímo nepoškodí, je nutné si dávat pozor jen na účinné chemické konzervanty, jako je kyselina benzoová či oxid siřičitý.
Chuť a vůně
To je divný, dostal jsem kombuchu a smrdí to octem, to se zkazila? Ne, kombuchové společenství je postavené kolem octových bakterií Komagataeibacter, Acetobacter a Gluconobacter. Tyto bakterie nápoj přirozeně zakyselují produkovanou kyselinou octovou, kvůli které tu dobrotu pijeme. Zakyselování každý ferment zabezpečuje proti zkažení.
Musím to pít tak hrozně kyselé? Ne, nemusíte, hotový nápoj má být příjemně kyselkavý, v průběhu prvního kvašení průběžně ochutnávejte a vypijte ho, až když je kyselý pro vás tak akorát. Nedbejte na rady ostatních chovatelů a nečekejte přesně stanovené časy. Vy jste chovatelé své vlastní kombuchy, vy máte své vlastní chutě, vy si je hlídejte.
Co s tím, když už je to moc kyselé? Slijte a používejte jako ocet, popřípadě řeďte před konzumací vodou/sodovkou/čajem. Rozhodně se nepřemáhejte a nepijte koncentrovaný ocet, ať si nepřekyselíte žaludek a nepoleptáte sliznice. Jako zákvas při zakládání várky používejte nápoj, který pijete s chutí. Pokud byste zakládali várku s hodně kyselým zákvasem, bude nápoj brzy také hodně kyselý, protože do něj už na začátku uvedete hodně kyselin.
Jak upravit chuť?
- pokud chcete nápoj sladší, fermentujte kratší dobu nebo sypte na vstupu více cukru
- pokud chcete nápoj sušší, fermentujte déle nebo sypte na vstupu méně cukru
- pokud chcete nápoj kyselejší, fermentujte déle
- pokud chcete nápoj trpčí, dělejte silnější čajové výluhy (klidně mnohahodinové)
- pokud nápoj prokysává příliš rychle, používejte menší množství zákvasu pro start příštích várek, tlustá celulózová placka plovoucí na hladině je účinnou brzdou v přístupu vzduchu a tudíž kysání; odkrytá hladina způsobuje rychlé kysání; kontrolujte, jestli jako zákvas už nepřiléváte příliš silně prokysaný octovatý nápoj, tím byste si vnášeli hodně kyseliny už na počátku fermentování; berte v potaz i kyseliny, které do vašeho nálevu uvádíte ještě před fermentací — týká se to hlavně ibiškovo-šípkových odvarů; řiďte se chutí, soustavně od prvního dne naložení a po celou dobu kysání ochutnávejte brčkem a upravujte poměry tak, abyste byli spokojení s úrovní kyselosti vy.
Kdo chce méně cukru v hotovém nápoji, nemusí nutně čekat dlouho na zpracování veškerých 7 % cukru bakteriemi, to vede k vysoké kyselosti. Stačí sladit čaj dle výše vložené kalkulačky třeba jen 5 nebo 4 procenty a pak fermentovat jen den či dva: nápoj bude suchý a zároveň ne hrozně kyselý.
Nečekejte na žádné časové mezníky z návodů. Soustavně ochutnávejte a nápoj slévejte a pijte v momentě, ve kterém chutná vám. Nedává smysl čekat podle cizí rady pokaždé týden, když je to pokaždé za týden prokysané napadrť. Každá odnož kultury je jiná, každá má jiný výkon v produkci kyselin.
Častým dotazem je i nežádoucí hořká chuť výsledného nápoje, nicméně nic hořkého při kvašení touto kulturou nevzniká a pravděpodobně tazatelé zaměňují hořkost za vjem trpký nebo suchý (čili postrádající cukr). Trpkost eliminujete kratší dobou louhování čaje a/nebo menší koncentrací čajového výluhu (viz kalkulačka), suchost eliminujete doslazením. Skutečně hořká chuť by musela pocházet z chmele, pelyňku, hořce, puškvorce nebo dokonce bitrexu, kterým se denaturují alkoholové čističe, které snad v kuchyni při fermentování nepoužíváte.
Jak dlouho hotový nápoj vydrží uložený? Nemůže se zkazit? Platí zde to samé, jako u všech jiných fermentů: jídlo a nápoje si lidé zakysávají proto, aby jim vydrželo déle. Když se proces zakysání podaří, je jídlo díky kyselinám od bakterií zakonzervováno a ochráněno proti patogenům na dlouhé měsíce a roky. Nezabijeme-li bakterie nějakou stabilizační technikou (konzervant, pasterizace), budou v nápoji vyrábět své kyseliny, plyny a alkoholy tak dlouho, dokud budou mít k dispozici cukr. Chuť se bude měnit do kyselé a suché, což znamená bezpečí. Oproti běžným potravinám, kterým odtikává trvanlivost a krátí se, je u živých fermentů přibývající čas naopak výhodou a trvanlivost se soustavně prodlužuje.
Kombucha je občas cítit zatuchle, jako po čpavku, co s tím? Z nepříjemných zápachů většinou vnímáme negativně síru (v nápoji není nijak významné množství jako v brukvích a ředkvích), a jednodušší dusíkaté (čpavkové) sloučeniny z rozkladu bílkovin. Třeba kopřivy jsou na dusík bohaté, proto jícha tak hrozně smrdí. Králíkárnou smrdí z potravin i fermentované tofu, sójová kostka meju, přezrálý tempeh, sýry či surströmming a všechno je to normálně jedlé. U kombuchy se to stává tehdy, když 1. fermentace s plackou moc nevětrá (láhev je uzavřená nebo placka hodně tlustá). Pokud na tento neduh netrpí váš kombuchový spolek soustavně a není to nesnesitelné, není potřeba to řešit.
Nápoj je cítit po kvasnicích, co s tím? Pekařské kvasnice jsou ty samé kvasinky, které létají kolem nás a kontaminují vaše kombuchy, takže šumí a obsahují trochu alkoholu. Pro svoje potřeby produkují kvasinky také poměrně velké množství B vitamínů, které jsou typicky cítit. Není potřeba to řešit.
Druhá fermentace
Co je to 2F? To je neodborná a nijak nestandardizovaná hantýrka, kterou používají jako zkratku diskutující ve skupinách. 1F je první kvašení sladkého čaje v láhvi překryté ubrouskem s celulózovou plackou, při něm se nápoj promoří organismy a zakyselí. 2F je nepovinný druhý krok, při kterém se nápoj bez placky stočí do láhví, ve kterých dále kvasí s přídavkem nebo bez přídavku dalších přísad a bez přístupu vzduchu pro dosažení další chuti, vyšší alkoholovitosti a nasycení nápoje vznikajícím oxidem uhličitým.
Co se při sekundární fermentaci v uzavřené láhvi děje jinak oproti primární? V první láhvi s plackou má mikrobiální společenství k dispozici aspoň povrchový kyslík, který potřebují octové bakterie, tudíž se v placce množí, přistavují ji a vyrábějí kyseliny. Ostatní organismy pracují tak, jak v daný okamžik umí. Po slití do láhví a zamezení přístupu kyslíku se změní životní podmínky v neprospěch octových bakterií (omezí své kysání), kdežto alkoholové kvašení, popřípadě mléčné kysání pokračuje. Žádné organismy se přelitím nezničí, jen se částečně omezí nebo naopak stimuluje růst určitých skupin organismů a tudíž i tvorba metabolitů (plynů, alkoholů, kyselin).
Druhá fermentace patří do chladu nebo do tepla? Podle vašeho uvážení. V teple všechno pracuje rychle, v chladu pomaleji. Chladnička ale fermentaci nezastaví, i v chladničce mohou alkoholové kvasinky za určitých podmínek vyrobit nadměrné množství CO₂!
Je druhá fermentace nutná? Ne, při fermentování není nic nutného, rozhodujete se podle svých preferencí a představ o chuti. Prokysaný a mírně perlivý čaj z první fermentace je sám o sobě skvělý a není potřeba s ním dělat nebezpečné alkoholové kejkle. Čajová kombucha je nejlevnější, nejrychlejší a sám o sobě nejjednodušší fermentovaný nápoj.
Můžu použít sušené, mražené nebo kompotované ovoce, zavařeniny, džusy, freshe? To je skutečně nejčastější dotaz u všech fermentů a neexistuje důvod, proč byste nemohli. Je to pořád jen ovoce a v případě zavařenin přidaný obyčejný cukr. Dokud nejsou přítomny chemické konzervanty (kyselina benzoová apod.), můžete spotřebovávat cokoliv z toho, co máte doma, jde jen o vaši preferenci chutí a textur. Bakterie sežerou všechno. Kyseliny z džemů a sirupů se přičtou v chuti ke kyselinám produkovaným fermentací, počítejte s tím a průběžně ochutnávejte.
Mixovat ovoce? Nebo celé? Převařovat kvůli kontaminaci? Ne, žádná úprava není nutná, stačí nakrájet a hotovo. Mixované nebo strouhané ovoce zaroste do celulózy. Pokud to chcete, mixujte a strouhejte.
Nebublá, neperlí ani nešumí. Proč? S bubláním každého domácího fermentu se to má jako s chlebovým kváskem. Produkci plynu zajišťují alkoholové kvasinky, které poletují všude kolem nás a nejde se jich zbavit, do nápoje je stačí jen pozvat. V kombuše nesnášejí, když jim nedáváte cukr, necháváte nápoj při 1. fermentaci v láhvi s plackou příliš zakyselit a nepoužíváte zákvas z předchozí várky. Kvasinky se vám do nápoje zase vrátí, když
- budete běžně sladit vstupní čaj chystaný na první fermentaci 7 % cukru,
- budete používat 10 a více procent zákvasu (klidně i 50 %, pokud není extrémně octovatý),
- budete používat dost silné čajové výluhy,
- už do první fermentace pod placku umístíte kousky ovoce nebo chemicky neošetřené slupky, ty jsou na divoké kvasinky bohaté a budou placku nadnášet,
- nebudete čekat při první fermentaci na brutální octové prokysání, tzn. budete první fermentaci ukončovat a zakládat novou tehdy, když bude nápoj jen příjemně nakyslý,
- v průběhu třídenní primární fermentace třeba jednou denně vyndáte placku, přelijete nápoj z výšky do totožné nádoby, aby se do něj zamíchal vzduch a placku zase vrátíte; kyslík stimuluje kvasinky k množení.
Napěstování kvasinek a udržování jejich vysokých počtů v primární láhvi je nutným předpokladem pro nasycení nápoje bublinkami v uzavřených láhvích při druhé fermentaci. Více napovídá článek Otázka bublavosti.
Musí se do druhé fermentace přidávat další cukr kvůli bublavosti? Pokud ho zbyl dostatek z první fermentace, nemusíte další přisypávat a kvasinky ho budou v uzavřené láhvi dále spotřebovávat. Nemáte-li namnožené kvasinky z první fermentace, nepomůže vám jakékoliv doslazování druhé fermentace. Správnou sladkost při stáčení a přípravě druhé fermentace poznáte jednoduše po chuti: nápoj nemá být ani zcela suchý, ani přeslazený. Vše mezi tím je OK.
V jak velkých láhvích se nechává dokvasit druhá fermentace? V běžných objemech 0,5−2 l. S rostoucím objemem roste i nárok na pevnost obalového materiálu.


Můžou skleněné láhve vybuchnout přetlakem při druhé fermentaci? Jistě, děje se to. Zvlášť tehdy, když se pokoušíte napodobit uživatele sociálních sítí, kteří vystavují šumivé a napěněné barevné nápoje s přídavkem ovoce — tehdy mají alkoholové kvasinky k dispozici jednoduché cukry a spoustu dusíku, množí se, vytváří přemíru CO₂ a alkoholu, což je příjemné v nápoji, ale ne tolik při výbuchu. Riziko je menší, pokud sladíte na vstupu málo a nepřidáváte při dokvášení žádné ovoce.
Vždy, když se toto téma v diskusích objeví, rozdělí se diskutující do dvou táborů: prví tábor se obává hnusů, které by se mohly do limonády uvolňovat ze zlých PET láhví, a proto fermentuje vysokotlaké granáty ve skle, druhý tábor preferuje bezpečnost a používá PET láhve schválené pro styk s potravinami. Zde je přehled nehod, které se lidem doma staly se skleněnými i plastovými láhvemi, kulatými i hranatými, tenkými i tlustými, došlo na úrazy. Povšimněte si, jak všichni přidali ovoce.




















Kompletně jsem tuto problematiku zpracoval do článku, kde uvádím všechny omyly, mylné návody a argumentaci proti tlakovému dokvášení ve skle, PET je bezpečnou cestou.
Radím nepořádat hon na perlení, které je tolik populární na sociálních sítích. Nápoj je dobrý i bez ovoce a bez alkoholů, s jemným perlením, které se dá připravit už v otevřené láhvi při první fermentaci, když je dostatečně tlustá celulózová placka a aspoň trochu napěstované kvasinky v základním nálevu.

80 komentářů
Krásně jednoduše a stručně vytvořené. ?
Díky ?
Paráda… ???. Děkuji
Šikovné, vše na jednom místě bez závanu pochybností ?
Pecka, skvěle napsané, tolik užitečných informací. A mockrát jsem se i upřímně zasmála:)) díky! Více vás takových! Amen
Tohle je přesně to, co jsem potrebovala! Moc dekuji
Moc děkuji! Velice mi to ulehčilo život i chov 🙂 přeji pevné zdraví a vím na koho se obrátit do budoucna v případě přednášky.
Děkujeme za polopaticky vysvětlené základy a vyjasněné nejasnosti, člověk to aspoň může brát pohodově a nehrorit to tolik, jak to někdy v diskuzích na fb čte.…chce to klid a radost. Díky díky, jen tak dál
.… paráda, idu to prubnout 🙂
Velmi děkuji, skvěle provedený návod!!
Poučné a hlavně bezvadně napsané.Čtení článku mě vážně bavilo.Fajn humor
Jestli to Zuza vydržela celou hodinu, tak má obrovskou pochvalu před bublajícím kvašákem a salutujícími streptokoky! 😀
Dobrý den.Mohu scoby která byla vypěstována v černém čaji. Zalít čajem zeleným?
Čaj jako čaj: stejná bylina Camelia sinensis. Článek to pokrývá touto formulací „Na různé substráty nepotřebujete různé kultury. Red rumi, jun a další jsou pořád jen octová kombucha. Když máte jednu, máte je všechny. Snadno je převychováte.“
To je krásný narazit na svoji placku v obrázcích. Měla jsem z toho velkou radost. Skvělý článek! 🙂
Snad líp napsané popsané jsem to nikde nenašla, velké díky ??
Moc děkuji za úžasný sumář rad a názorů! ?
Zdravím, díky za výtečné shrnutí problematiky čajové medúzy!
Chybí mi odpověď jen na jedinou otázku: jakým fíglem dosáhnout té krásné kompaktní placky, kterou jsem onehdá dostal z Vašeho e‑shopu? To jen ve mně hlodá zvědavost, protože jinak se mi s tou mojí ošklivou potvorou daří velmi dobře :-).
Tak to není žádný fígl, to je jednoduché stání promořeného nálevu popsané v Chovu — jak si vypěstovat z malé velkou. Bohužel už teď je text jeden z nejdelších na blogu a pro mnoho chovatelů už je tak dlouhý, že je pro ně obtížné ty informace vyčíst. Třeba jen tuto problematiku bychom mohli zopakovat ještě mnohokrát na dotazy, které někdo nenašel:
„Jak vypěstovat celulózu kulatou?“
„Jak vypěstovat celulózu hranatou?“
„Jak urychlit stavbu?“
„Můžu z velké celulózy vykrájet vykrajovátkem menší?“
„Co dělat, když je celulóza moc tlustá?“
„Jak často ji mám vyhazovat a začínat od začátku?“
„Můžu mít dohromady starou celulózu s novou?“
„Můžu mít v nálevu dvě? Nebo tři?“
Žádná z těchto otázek není přímo zodpovězena, všechny odpovědi přijdou správnou dedukcí a interpretací čteného textu. Vždycky bude chybět výslovná odpověď na nějakou osobní formulaci otázky.
S kulturou žijte, manipulujte, zkoušejte a když neuděláte základní chyby, nakonec se vám všechno otevře samo, i bez dílčího doptávání předem. Na blogu se snažíme vést ne k závislosti na našem vedení, ale ke zvídavosti, samostatnosti a prozkoumávání jídla.
Krásná práce, velké díky!!!
Dobrý den, moc děkuji za perfektní článek, konečně jsem si udělala jasno a pochopila jsem principy v kvašení kombuchy ???. Olga.
Jsem nadšen, že to někomu poslouží dál než ke získání dílčí odpovědi. Moc se mi líbí to slovo principy. Díky, že nás čtete!
Dobrý den,
děkuji za čtivý a srozumitelný návod. Zdravý selský rozum je v dnešní době vzácná komodita.
Moc děkuji, nicméně toto není produktem selského rozumu, tím se nedá vymyslet mnoho. Stálo to studium (psaného textu), studium (mluveného slova) a zase studium (relevantnosti a platnosti závěrů). Díky že nás čtete!
Dobry den, jsem zacatecnik a zajimalo by me, jestli de kombuchou otravit? Nejakou spatnou pripravou?
Otázka je v úhrnu z odpovězena, viz Pojí se s konzumací nějaká závažná zdravotní rizika? Prý došlo i k otravám!
Dobrý den, chtěla jsem se zeptat,jestli se po pravidelném každodenním pití nápoje, má udělat přestávka v užívání?Pokud ano,tak jak dlouhá.Děkuji za odpověď a také za smysluplný a pochopitelný článek.
Toto je pravda také častý dotaz, děkuji za jeho připomenutí. Doplňuji do oddílu Konzumace a zdraví
Vláďo, parádny článok. Ďakujeme Ti za rozšírenie obzorov. Čo sa týka pretlakovania vo fľašiach, sú už „špeciálne“ štuple, ktoré to riešia. Majú membránu, ktorá prepúšťa pri určitom tlaku. Avšak nerieši to pretekanie. Krásny deň.
Vláďo, moc díky za obsáhlé shrnutí celé kombucha problematiky záživnou formou Q&A. Měl bych k tomu také jeden konkrétní dotaz. Dělám druhou fermentaci, protože mne v kombuše baví ten ovocný rozměr. Na druhou stranu mi ale vadí obsah alkoholu v kombuchovém nápoji a tudíž bych jej rád minimalizoval.
Je prosím platná moje domněnka (založená na množství přečtených článků), že alkohol na úkol různých ovocných kyselin v kombuchovém nápoji vzniká spíše, když:
— při 2F přidám hodně cukru (např. hodně sladkou ovocnou šťávu typu hroznové, rozmačkaný banán apod.?) a tím pádem se rychle rozjede kvasinková aktivita cukr -> alkohol + CO2?
— při 2F nechám uzavřené víčko, tj. proces je spíše anaerobní a tedy není dostatek kyslíku k přeměně alkoholu na kyseliny?
— při 2F nechám uzavřené víčko a tedy stoupá obsah CO2 v nápoji, jež brzdí bakterie v přeměně alkoholu na kyseliny?
Na základě tohoto nyní zkouším 2F bez uzavřeného víčka. Ocením ale jakoukoliv radu, či doporučení obecných principů, které při výrobě dodržet k tomu, aby kombucha měla co nejmenší obsah alkoholu.
(Pozn. nemám v kuchyni GC, takže obsah alkoholu určuji pouze senzoricky/pocitově).
Bohužel každý domácí kutil se zdravou dávkou sebereflexe musí prohlásit: nevím. Bez laboratorního vybavení a příslušných znalostí se jedná jen o velký úhrn teorie nad velmi nespecifickým souborem mikroorganismů, který si, zatímco my si tu fantazírujeme, dělá, co chce. Mohl by o tom vědět více Tom Joybucha Hasík, ale stejně bude vždy podmínkou měření alkoholu některou z těch složitých metod.
Moc děkuji za čas, který jste nám věnoval a tohle všechno přehledně sepsal. První dva pokusy s násadou koupenou ve zdravé výživě mi zplesnivěly a díky informaci zde, že ze začátku, kdy déle trvá, než se proces nastartuje, je možné nádobu úplně uzavřít, se mi podařilo překonat ty první choulostivé dny a týdny a pomalu postupně už navyšuji množství čaje. Taky jste mi objasnil to s tím kovem a nerezem, což mi dlouho vrtalo hlavou — proč by vadil nerez, když je to tradiční gastro materiál? Díky ještě jednou! Spousta věcí, co jsem si přečetla v součinnosti se zdravým selským rozumem začíná dávat smysl.
Občas když na tím přemýšlím, mi v hlavě jede vývojový diagram, který pokrývá ten proces od začátku s tenkou blankou ve dvou decích čaje až po radosti kolem F2, vybuchující skleněné lahve a podobně. Stálo by to za to to rozkreslit:-)
Moc dík, ono to skutečně všechno do sebe časem zapadne, stačí se vším trochu delší dobu žít, nevzdávat se, vracet se k osvědčeným a dobře argumentovaným informačním zdrojům (vystačíme si s přírodovědou a chemií ZŠ) a pak už je to brnkačka.
Vývojové diagramy dneska asi už nikdo číst nebude, lidé potřebují videa nebo názorné animace a já to chápu. Taky bych to sám z diagramu nevstřebal..
Zdravím. Kombuchu kvasím už několik let. Velká spokojenost, zatím bez karambolu. Před časem mě napadlo, lépe řečeno, bylo líto nadměrného množství vzniklé „houby“. Když mohu tak obdaruji, nebo nakrájím na jemné nudličky a přidám do asijského jídla, kde se přidává Jidášovo ucho 😂😂
To je dobrý nápad! Celulóza je jedlá, i když nestravitelná, pomůže nastavit objem jídla, zasytí a možná že si na ní pošmáknou nějak bakterie tlustého střeva. Do sladkokyselých asijských jídel se to myslím báječně nabízí. Nadměrně kyselé chuti by se dalo zbavit naložením do čisté vody.
Dobrý den, téměř pokaždé se mi v rámci f2 (naposled s malinami či mučenkou) vytvořila nová scoby. Je to v pořádku?
Je to v pořádku: „Chováte octové bakterie, které konzumují cukr, produkují ocet a celulózovou vrstvu na hladině, to vše za asistence alkoholových kvasinek, které konzumují cukr a produkují alkohol a CO2.“
Kde jsou kombuchové bakterie, tam staví celulózu. Dokud bakterie nezabiješ a dokud budou mít co jíst a aspoň trochu kyslíku, budou stavět.
Zdravím. Chybí mi tady jedna otázka. Co léčivé bylinky typu meduňka, máta a mnoho dalších nebo třrba dnes populární rýmovník. Je možné kombuchu dát do takového čaje? Bude to fungovat? Nebo je to závislé právě na tom teinu a kofeinu. Od některých lidí na netu co to prodávají, se mi dostalo odpovědi, že to možné je. Jsou s tím nějaké zkušenosti?
Na našem blogu vyzýváme: neptejte se a nečekejte odpovědi, buďte zvídaví a zkoušejte — jedině tak se dozvíte, jestli vám to bude fungovat a vyhovovat. U kombuchy říkáme, ať vyzkoušíte jakékoliv byliny máte rádi nebo byste je chtěli upotřebit. Návod na eshopu praví: „Doplňky — pokud budete do fermentace přidávat další komponenty kvůli dochucení, např. citrusovou kůru, bergamotový či aromatický výluh z ovoněných čajů, koření, sušené ovoce,
bylinky, dbejte jen na to, aby byly čisté, a pokud je přidáváte do primární fermentace a navoní vám celulózovou placku, mějte v záloze odloupnutou záložní.“
Za Vaše shrnutí jsem moc vděčná. S kombuchou už kamarádím úspěšně asi rok, ale nezodpovězených otázek jsem stále měla dost. Ve vašich “otázkách a odpovědích” jsem našla vše, co mi za ten rok přišlo na mysl a dokonce i to, co mě vůbec nenapadlo řešit, ale je to velmi důležité viz. zbytkový alkohol v kombuše a vhodnost pro děti a těhotné.
Takže děkuji, tenhle článek byl pro mě nesmírně přínosný.
Děkuji, snažím se stát nohama na zemi! Pokud se dozvím něco nového od lidí, kteří dané problematice rozumí lépe (VŠ, akademici, lékaři, technologové), odpovědi reviduji, aby v nich nebyly blbosti.
Dobrý den,
předně díky za boží a vyčerpávající text.
Klasicky mám ovšem dodatečný dotaz. Při 2F se vždy tvoří nová scoby a výherce má ve sklenici vždy jednu „nechutnou“ slizovou ozdobu… Jasně, vyhodím, ale ! Nejmenovaný malý český prodejce kombuchy nic takového nemá, jeho nápoje obsahují slušnou dávku bylin a jsou bublavé a krásně průzračné. Jde tedy jen o důkladnou filtraci? Mně zatím nic nepomohlo 🙂
Děkuji !
Dokud se výrobce nezeptáme, tak nezjistíme, jak zajišťuje aspoň základní stabilizaci proti dalším mikrobiálním pochodům. Často to bývá tak, že výrobce nechá prokysat kombuchu velmi silně a takový zákvas pak používá při míchání limonád. Aby to nebylo ultrakyselé, tak to musí hodně zředit a kde je malý počet bakterií, tam nedochází ke stavbě 👉 to je ten klasický syndrom začátečníků, kteří si slabou kulturu utopí v příliš velkém množství substrátu a pak se dřív dočkají problémů než kombuchového růstu.
Nezbývá než jít za výrobcem a podívat se mu pod ruce, jak to vede a sytí, a pak to doma zvrtat úplně novým složitým způsobem. Stejně se ukáže, že to za tu práci nestojí a je jednodušší celulózové shluky průběžně vyhazovat.
Dobrý den, Vláďo,
díky moc za vaše texty. S kombuchou jsem začal asi před ctyřmi měsíci a je to výborná zábava. Začal jsem s kulturou ze zdravé výživy, ve které plavala tenká blanka celulózy. A podařilo se. Když teď kulturu posílám dál a jsem línej dělit celulózu, předám jen lahev se silným zákvasem, ideálně slitým ze dna lahve. Tak se chci zeptat:
1) Existuje riziko, že bych tím systematicky pžedával kulturu s tak nízkým podílem těch stavěčů celulózy, že by z násady vznikal ferment ale bez celulózové vrstvy?
2) Našel jsem hromadu literatury k optimalizaci nálevu, potažmo kultury, pro stavbu celulózy. Nikde se ale nemůžu dočíst, jaký vliv má celulóza na průběh fermentace. Získal jsem pocit, že se silnou celulózou zůstává víc plynů v tekutině, ale co se táká rychlosti fermentace, zdá se mi že vyměnit celulózu za víc zákvasu je v podstatě to samé. Narazil jste někdy na něco k vlivu celulózy na průběh fermentace? Nějaká vlastní pozorování?
Díky
Dík za zajímavé dotazy, Viktore. Já se nemůžu prohlásit za člověka, který do každého nálevu vidí a určí, co se kde děje, ale myslím si, že:
Abych pravdu řekl, tak se v tom zase až tak moc nešťourám a beru tu limonádu tak, jak běží a leží: když to šumí, tak mě to těší, když je to zticha, tak to neřeším, když je to kyselé, tak to naředím, když je to sladké, tak to ještě nechám. To je vše, co pro mne tohle pití znamená. Ze stejného důvodu nepředvídatelnosti a neřiditelnosti začali mlékaři používat na kefír selektované kefírové kultury, ne divoká konsorcia. Ještě navedu na složitost situace čerstvým článkem Ta pravá kultura.
Ahoj Láďo. Vzpomínás si jak jsem tě potkal na Andělu v Praze a rychlá debata se stočila k fermentům ( kam jinam že 😀 ) a jak mi sekundátní fermentace kombuchy z plastové láhve vymalovala byt? Vyhrál jsem nad hmotou a jejím nebezpečnym tlakem. Napadlo mně to vlastně čirou náhodou když se z mojí kombuchy stal granát, který jsem otevíral ráno před domem. Zrovna ten den jsem neměl nic jiného po ruce než prázdnou láhev od Mattoni kterou přítelkyně nechala na lince ( do něčeho jsem si musel načepovat dobrotu do práce ). Ta láhev ( je to Mattoni Sport ale mají to i jiné značky ) má jednu úžasnou vychytávku. Šroubovací víčko co vypadá jako dětský „dudlík“ ve kterém je silikonové kolečko s vyříznutým křížkem. Otočíte láhev vzhůru nohama, zatřepete…nic neteče. Silně zmáčknete nebo vytvoříte dostatečný podtlak…teče. Vynález za všechny prachy. Dokonalý jednocestný ventil. A pasuje na jakoukoliv libovolnou láhev od limonády. Naliju kombuchu, našrouboju „víčko“ a voala. Nečistoty nemohou dovnitř, ale plyny mohou nerušeně svým vlastním tempem prdět ven. Žádný nebezepčný tlak nebo vymalovaný pokoj. Všechno se reguluje svým přirozeným tempem samo. Ja vím, je to blbinka a asi jsem Ameriku neobjevil. Ale opravdu to funguje a nestojí to skoro nic. Zvažuji to otestovat i na další „vodní“ fermenty kde mně nelimituje úzké hrdlo. Tak zdar všem, a ať to bublá.
Davide perfektní nápad pro ty, kdo se nebojí kvasit v plastu. Bohužel potíž je právě s odmítači plastů, kteří za každou cenu tyto fermenty uzavírají do skla a na skleněné láhve tyto uzávěry nepasují. Inspirace je však velmi dobrá, díky, zahrnu to nejspíš do článku zpracovávajícího problematiku domácích granátů (s příslušným kreditem, pochopitelně 🙂 ).
Pošli mi na mejl prosím jestli máš fotky té kávové kalamity, dík!
Dobrý dem, super výživný článek plný selského rozumu. Jen mám otázku. Dělala jsem kombuchu teprve podruhé. První pecka, dobrá, kyselé tak akorát, placka pěkně vyrostla. Druhou jsem udělala stejně, nechala stejnou dobu, jen jsem nebyla doma a nešťouchala do ní. A při vyndání bylo ve všech vrstvách celulózy plno černých mini teček. Na pohmat jako písek? Je to ok? Moc děkuji za rady i za celý váš web 🙂
Takže propadlý čaj cedníkem? Fermentací určitě nevzniká na pohmat nic jako písek.
No nevím, cedím přes kávový filtr… Takže je to podle vás v poho. Dobře děkuji 🙂
Milý Vláďo,
takový článek jsem hledala dlouho. Díky moc. Když pominu vtip s jakým je napsaný 😀 tak mi osvětlil všechny důležité a podstatné aspekty, které jsem o kombuše nevěděla a vědět měla 😀 Nechci se nikoho dotknout, ale když jsem si jí nedávno pořizovala, trochu mi to podle některých návodů připadalo, že to bude svou náročností a péčí horší než další dítě 😀 Vaše webovky si ukládám do oblíbených a budu se těšit na příště. Juch. Lucie, Praha
Ohromné díky, že nás přátelé čtete. More to come!
Dobrý den, mohla bych se zeptat, proč tolik kombuše vadí kov a co se stane, pokud přijde s kovem do styku samotná houba nebo nápoj?
Doporučuji se vrátit k článku a pročíst ho, protože odpověď na kov je v něm obsažena, zrovna tak pojem „houba“, která není houba.
Dobrý den, mohu celulózu nacpat do menší sklenice než je ona sama s dvojnásobným množstvím sladkého čaje a trochou zákvasu a zazimovat v lednici do dalšího léta?
Nebo jak ji mám uchovat přes zimu, když nechci dělat kombuchový nápoj?
Mikroby je nutné krmit i v chladu, jen stačí s menší frekvencí než v teple. Čím déle budou mikrouši v chladu, tím odlišněji se budou chovat po vysvobození z lednice.
Držte se pokynů v otázce/odpovědi či PDF návodu. Děkuji ale za podnět, tento dotaz jsem rozvinul i na delší uložení.
Dobrý den,
často čerpám info o kombuše na Vašich stránkách a jaksi se mi nedaří ji dělat dobrou. 🙂
Chtěla bych se tedy prosím zeptat — často má kombucha chutná hořce. Nevíte, proč to tak je? Dodržuju recept, fermetuju ji max 7 dní, používám buď bílý cukr nebo třtinový, čaj kupuju bio zelený z Oxalysu nebo jsem teď nově pořídila od Sonnentoru opět bio zelený čaj, čaj louhuji podle receptu, cca 3 minuty. Napadlo mě, jestli by na to mohla mít vliv voda — doma totiž máme pouze změkčenou vodu ze změkčovače. Co si o tom prosím myslíte?
Děkuji za odpověď.
Kristýna
Už jsem si vícekrát ověřil, že lidé zaměňují hořkou chuť za různé jiné vjemy. Skutečná hořkost (pelyňková, chmelová, bitrexová) sama o sobě při kvašení nevzniká — fermenty nejsou nikdy hořčí než vstupní suroviny, se kterými jste začali.
Bohužel to nemůžu vyhodnotit, dokud bych výsledný nápoj neochutnal. Někdo hořkostí označuje suchost (čili absenci cukru po prokvašení), někdo zase trpkost (dlouze louhovaný a silně koncentrovaný výluh čaje, což zde asi není ten případ, když louhujete jen 3 minuty).
Doporučuju použít kalkulačku na poměry a pokud chybí sladkost, tak přisladit na začátku či na konci kvašení. Třtinový cukr je zbytečně drahý, Oxalisový nebo Sonnentorový zelený čaj je zbytečně drahý. Parádu uděláte i s obyčejnými surovinami za pár korun — výsledná chuť kombuchy na domnělé kvalitě vstupních surovinách zase až tak moc nezávisí. Stačí, aby byl čaj prostě jen dost silný (3 minuty bývají málo — ty jsou doporučené pro čaj, který se popíjí, ne pro čaj, který se kvasí), ale ne zase tak moc silný, aby vám už při zakládání várky roloval ponožky. Dejte vědět, jestli se to sílou výluhu a slazením upravilo. Věřím, že to tak bude.
Vládo Super!
Musím si prostudovat celej web. Zatím jsem nenašel nic tak uspokojivýho, jako je tvůj článek. Jelikož je to muj první článek co čtu, tak se mám na co těšit!
Dvakrát jsem se u čtení nekontrolovatelně rozřechtal !
Kombuše ZDAR!
Dobrý den,
mám dotaz. Před x lety jsem měla doma také kombuchu (budu-li mluvit o té celulozové placce) a vyráběla si ji. Pak dlouhá léta ne.
Nyní jsem si řekla, že si ji opět pořídím, ale jelikož mám doma zkvašený jablečný ocet před stočením a je na něm krásná octová matka, napadlo mne, že bych ji použila do čaje místo „kombuchy“. Říkala jsem si, že jde vlastně o totéž: octová matka = kombucha. Kvasinky a bakterie jsou ty domácí a jde jen o nastartování kvasného procesu.
Co myslíte, mám pravdu?
Zodpovídá to otázka Když mi vyrostlo něco podobného na octu, je to taky kombucha? — doporučuji k přečtení. Zkrácená odpověď: základ celulózotvorných octových bakterií je podobný, ne-li stejný, zbytek biodiverzity však stejný není (v octu tolik druhů nepřežije).
Velmi objemná dávka informací, nicméně skoro ve všech „odpovědích“ je psáno „nedá se říct, není dokázáno, je předmětem dohadů apod.“ Nevím vlastně proč bych měl kombuchu pít. Jen proto, že by mi mohla chutnat?
Především proto! A je také možné, že na sobě zpozorujete nějaký pozitivní efekt, což je v pořádku, ale my vždycky připomínáme, že osobní zkušenost je zpravidla nepřenosná a ten, kdo tento efekt vypozoruje, jej nemůže manifestovat jako univerzální benefit konkrétní potraviny či kombuchy. Z toho pak vznikají ty soupisky, které má na svém webu každý výrobce kombuchových softdrinků, protože ví, že to lidé chtějí číst, chtějí se tou vírou opájet. Více v článku Probiotický elixír zdraví.
Já to piju proto, že mi nechutná pivo, limonády ani čistá voda, pročež kombuchový nápoj je pro mě v podstatě odměna.
Moje kombucha mi produkuje větší množství nápoje, než jsem schopná spotřebovat. Mohu zpomalit kvašení tím, že kvasnou sklenici dám do chladu? Neprestanou pak některé organizmy fungovat a nápoj bude jiný?
Bude to podobné, jako s chlebem: není to kvásek, kdo vyprodukuje pekařovi dva přebytečné chleby za týden, je to pekař, kdo na ty dva přebytečné chleby zadělává.
Zarolujte nahoru ke kombuchové kalkulačce a nastavte velikost placky na takový rozměr, který vyprodukuje tolik nápoje, kolik si přejete. Pak svou placku okrájejte a ztenčete na potřebný rozměr a pokračujte běžným způsobem. Tím to celé prostě přeškálujete na menší množství. Obejdete tím i ty otázky na zachlazování (ke kterým máte tu teorii správně).
Dobrý den,
chtěla bych se zeptat, jakým způsobem můžu „převychovat“ kombuchu? Kombuchu dávám do černého čaje, ale láká mě Red Rumi kombucha do šípkového/ibiškového čaje.
Nehledejme složitosti tam, kde nejsou: prostě jen začnete lít bakteriím extrakt z jiných bylin, zachovejte poměry dle kalkulačky.
Je to asi taková věda, jako když trochou žitného kvásku jednoho krásného dne rozkvasí pekař pšeničnou mouku s vodou. Bakterie a kvasinky se zakousnou do čehokoliv — chtějí prostě jen uhlík, dusík a pár stopových prvků. To jen lidé si myslí, že je v těch nálevech nějaký zásadní rozdíl, protože vidí rozdílné barvy. Ne nadarmo máme na knížce napsáno, že kvašení není raketová chirurgie. Naopak — je jednodušší, než si začátečníci myslí.
Dobrý den, děkuji moc za objemný článek plný užitečných informací :). Přesto bych měl jeden dotaz a to ohledně používání zákvasu do další dávky (očkování). Je používání zákvasu pro další dávku podmínkou nebo si vystačím pouze s plackou (sladím na 7%)? Aktuálně si dělám kombuchu ve dvou sklenicích a po cca 3 dnech první fermentace už je příjemně kyselá, ale „brutálně“ šumivá. Šumivou po první fermentaci ji mám za mě opravdu moc, kolikrát mám pocit, že piju „burčák“ (co se týká alkoholu). V jedné sklenici jsem teď zkusil udělat novou várku pouze s plackou a po 3 dnech byla obdobně kyselá a méně šumivá — což mi vyhovuje, ale chci se ujistit, zda je zákvas nějakou podmínkou nebo je to potřeba jen v případě např. horších podmínek pro kvašení (chlad, bakterie v ovzduší apod.). Předem děkuji.
Odpověď vyplývá z vysvětlivek k otázce Proč se používá placka i zákvas? Je-li používání zákvasu cestou k šumivosti, pak je používání menšího nebo žádného zákvasu cestou k menší šumivosti, takže dedukce byla správná. Oba směry vedení jsou popsány v článku Otázka bublavosti.
Dobrý den,
chtěla bych se zeptat, zda je možné,že je nálev hotový po 1,5 dni? Přijemná kyselost i perlivost. Je fakt, že po větsinu dne je v místnosti 24 C. Není to až moc rychlé? Nebo ta rychlost nevadí? Na povrchu se tvoří docela dost pěny-používám nálev z ibiškového čaje.
Předem děkuji za odpověď
Mnoho chovatelů nebere v potaz, že už při zakládání fermentu uvádějí do tekutiny nějakou kyselinu a pak jsou překvapení, že je to velmi brzy kyselé akorát, anebo za delší dobu kyselé příliš. Týká se to buď používání překysaného zákvasu z minula, anebo právě ibiškových nebo jiných kyselých surovin. Z ibišku dodáváte do vody ještě před započetím kvašení kyselinu šťavelovou, citrónovou, jablečnou, askorbovou a další, pročež vaše octové bakterie pak už nemají příliš mnoho práce s vyprodukováním takového množství kyseliny octové, aby to jazyk vyhodnotil jako hotový nápoj. Není na tom nic v nepořádku, dokud vám to chuťově vyhovuje. Kdo začíná s neokyseleným obyčejným sladkým čajem, ten si na kyselost od octových bakterií počká o trochu déle.
Dobrý den, Vláďo,
moc děkuji za skvělý článek ve všech směrech. Škoda, že jsem ho nenašla dřív, než se z mé kolonie stalo zjevně městečko duchů, kde neprobíhá tvorba nové placky a kvasící proces jde velmi velmi pomalu. Ráda bych se proto zeptala, jestli je vůbec ještě možné život na placce znovu nastartovat nebo se mám smířit s tím, že bude třeba nová? A rovněž bych se ráda zeptala — když máme rádi méně prokvašený nápoj, jak se dříve či později do podobného stavu opět nedostat? Vždy si nejdřív udělat starter v menším množství a až pak přilít další čaj například? Vím, že píšete testovat testovat, ale nerada bych zase skončila s vyčerpanou kolonií, tak se přeci jen raději zkouším zeptat…
To se bohužel nedá zodpovědět takto v jednoduché odpovědi, protože bych si kompletně musel nechat předvést způsob vedení kultury u vás v domácnosti, abych mohl odhalit nějakou technologickou chybu. Už jsem se dobře poučil, že moje představivost zdaleka neodhadne kreativitu domácích fermentariánů a jak mi přijdou některé postupy samozřejmé a jednoduché, tak je může někdo obrátit úplně naruby.
Pořád platí, že máte v ruce nějaké množství nějakých druhů mikroorganismů, které musíte nakrmit a nechat v substrátu pomnožit a v momentě, kdy mají hodně snědené krmivo, jsou jich vysoké počty a vyrobili hodně metabolitů, tak jim klícku zase poklidíte a dáte jim znovu nažrat, přičemž je nesmíte naředit tak, aby tam zbyly poslední dva, kteří se do příštího krmení nestihnou rozmnožit na desítky miliard. Ano, proto se dělají zákvasy, kde se promořuje nahusto v malém množství substrátu a tím se pak očkují větší množství.
A nakonec připomínám: ničeho není škoda. Kombuchové kultury nejsou vzácné. Jsou to úplně bezcenná společenství octových bakterií, které má každá pátá domácnost a poletují kolem nás ve vzduchu. Kdykoliv jde chov úplně vylít a začít znovu s jinou, třeba daleko promořenější partou octovek, se kterou bude příští run mnohem zábavnější a životaschopnější.
Dobrý deň čítala som vaše články len ja mám problém že moja scoby pláva pol hore a polka jej je dole . Ďalej chcela by som vypestovať krásne hrubú placku ale bojím sa to zavrieť aby mi nebuchla fľaša . Nerozumela som poriadne zavrieť ok nie je problém ale nebuchne mi to ? Ako často to otvárať , dávať tam sladký čaj , alebo ju nechať v zákvase ? Lebo keď nechám v zákvase moje placky tak zhora sa tvorí ďalšia ale keďze polka placky mi pláva dole a polka hore tak z toho vzniká akási hrča v strede je hrubšia a po bokoch tenká . Viete mi prosím poradiť mám z toho zmätok. Ďakujem
Uberte plyn, nezahlcujte se problémy, které ještě nenastaly a pokračujte.
V textu stojí, že je úplně jedno, kde se placka nachází a jak je tvarovaná, na tom nezáleží. Při čekání na přístavbu to nebouchne, protože to zkysne tak, že kvasinky usnou a nebudou produkovat žádné významné množství CO₂. Uzavřít to můžete i neprodyšně fresh fólií a na stavbu počkat. Řiďte se otázkou Jak si vypěstuji z malé placky velkou?
Ďakujem veľmi kras s hneď mi je od vás všetko jasnejšie . Ďakujem veľmi krásne .
Krasny clanek! Diky za nej 🙂 Dotazek, snad jsem nepochopila/prehledla:
1) Mohu pouzivat nadobu s kohoutkem, z ktere si kombuchu odliji a zkratka rovnou pridam novy slazeny caj, nebo musim nadobu po kazdem turnusu umyt?
Delala jsem prvni varku, F1 tyden — chutne, pak jeste ncca 4 dny F2 s ovocem, lahve jsem odrihavala, takze nebyla tak perliva, vysledkem bylo okolo 10 dni fermentace a napoj nebyl nijak zvlast kysely ani perlivy, rikam si, ze to trvalo dost dlouho, mame tady okolo 20 stupnu… bylo to tedy asi nedostatkem starteru nebo mala kyselost? Diky!
Na způsobu vedení není nic pevně dáno, nemusí se dodržovat žádný konkrétní rituál a průtokové dolit-upít-dolít-upít je samozřejmě jednou z běžných praxí; kombuchové láhve ani skleničky s chlebovým kváskem se vymývat můžou a nemusí, protože je zabezpečuje samotný ferment a nekazí se. Zde špína není špína, viz otázka Musím láhev vymývat a vyvařovat?.
Rychlost a intenzita prokysávání odvisí od aktuálního poměru typů mikrobů (zda jsou namnožené alkholové či kyselinotvorné) a jejich počtů. 7+4 dny jsou dost na to, aby byl nápoj dost kyselý a alkoholický, je-li kultura výkonná a mikrobů hodně. Pokud se při takových čekacích dobách nic neděje, máte kulturu naředěnou a tudíž nevýkonnou. Viz na začátku Ztracené bakterie a otázka Jak se pozná aktivní kultura?
Dobrý den, Vláďo,
děkuji Vám za článek! Řeším problematiku ohledně konzumace dítětem. Jelikož s manželkou každodenně pijeme tento nápoj, láká to i naše děti (věk 3+) a moc jim chutná! Z tohoto důvodu jsem přešel z černého čaje na zelený a snažíme se to dětem hodně ředit. Manželka má strach ohledně možného alkoholu v nápoji. Jaký na to máte názor?
Děkuji.
Zde bych musel opsat to, co už v článku je v odpovědi Je kombucha vhodná pro děti, řidiče, abstinující alkoholiky či těhotné a kojící ženy? Můžu ji při užívání léků, antibiotik?.
Co se týče přechodu z černého čaje na zelený, tak to vůbec nic neznamená, ani jeden není pro děti nebo pro dospělé škodlivější nebo zdravější.